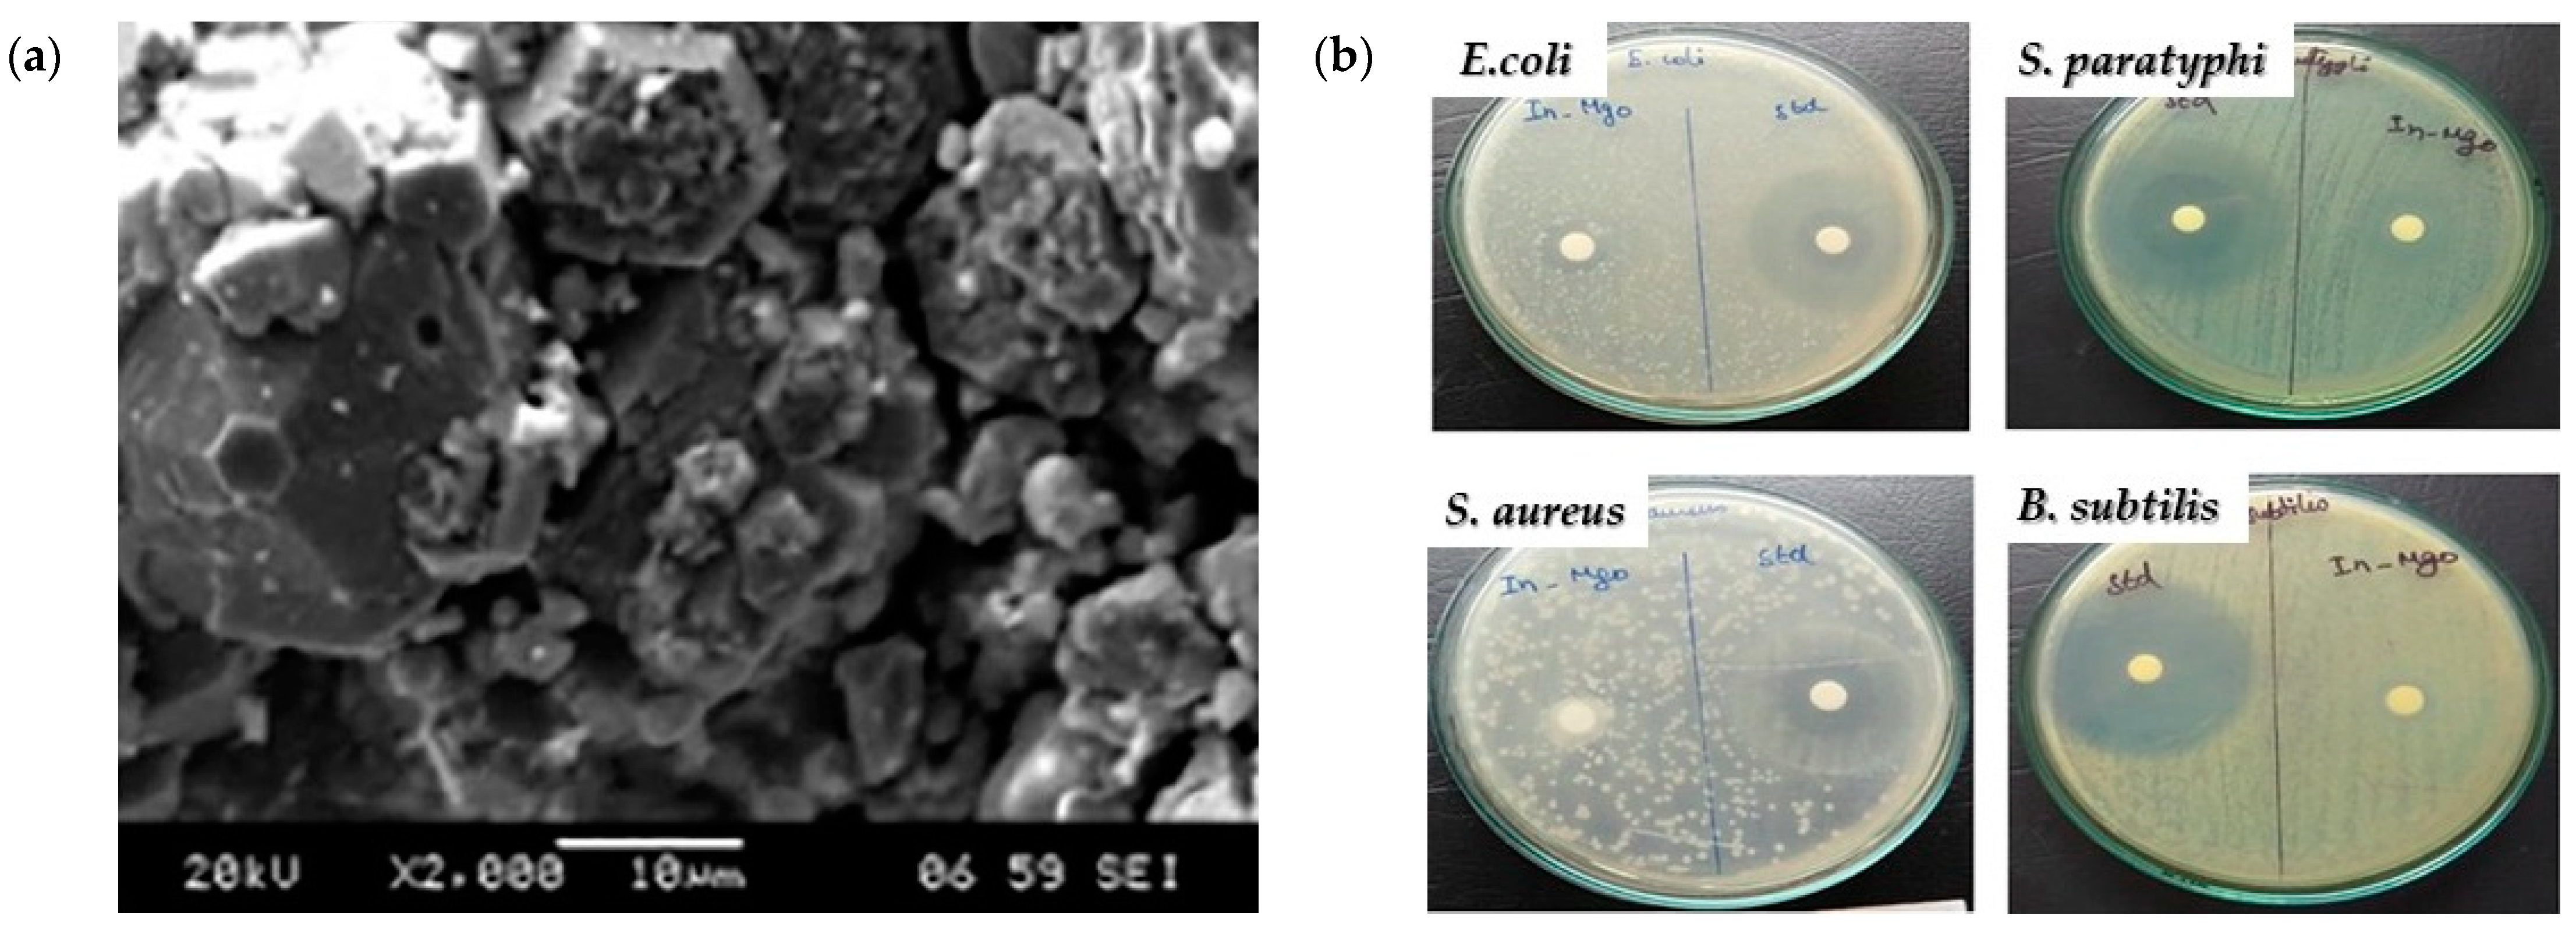
Crystals 14 00215 g010

Magnesium Oxide (MgO) Nanoparticles: Synthetic Strategies and Biomedical Applications
Abstract
1. Introduction
2. Distinct Attributes of Nanostructured Magnesium Oxide
3. Synthetic Approaches for the Production of MgO Nanoparticles

3.1. Co-Precipitation Synthetic Approach
3.2. Sol-Gel Synthetic Approach
3.3. Solvothermal/Hydrothermal Synthetic Approach
3.4. Combustion Synthetic Approach
3.5. Biosynthesis or Green Synthetic Approach
4. Biomedical Applications of MgO Nanoparticles
4.1. Antibacterial Activity
Mechanism of MgO Nanoparticles’ Bactericidal Activity
4.2. Antifungal Activity
4.3. Anticancer Activity
4.4. Antioxidant Activity
4.5. MgO-Based Biosensors towards Diabetes Detection and Treatment
4.6. Tissue Engineering Applications
4.6.1. Bone Tissue Engineering
4.6.2. Skin Tissue Regeneration
4.7. Bioimaging Applications
4.8. Drug Delivery Applications
5. Current Limitations
5.1. Toxicity of MgO Nanoparticles
5.2. Oxidative Stress
5.3. Dissolution
6. Future Prospects
7. Conclusions
Author Contributions
Funding
Data Availability Statement
Conflicts of Interest
References
- Singh, T.A.; Das, J.; Sil, P.C. Zinc oxide nanoparticles: A comprehensive review on its synthesis, anticancer and drug delivery applications as well as health risks. Adv. Colloid Interface Sci. 2020, 286, 102317. [Google Scholar] [CrossRef]
- Thakur, N.; Thakur, S.; Chatterjee, S.; Das, J.; Sil, P.C. Nanoparticles as smart carriers for enhanced cancer immunotherapy. Front. Chem. 2020, 8, 1217. [Google Scholar] [CrossRef] [PubMed]
- Thakur, N.; Manna, P.; Das, J. Synthesis and biomedical applications of nanoceria, a redox active nanoparticle. J. Nanobiotechnol. 2019, 17, 84. [Google Scholar] [CrossRef] [PubMed]
- Tejwan, N.; Saha, S.K.; Das, J. Multifaceted applications of green carbon dots synthesized from renewable sources. Adv. Colloid Interface Sci. 2020, 275, 102046. [Google Scholar] [CrossRef] [PubMed]
- Thakur, N.; Das, J.; Sil, R.C. Emerging role of redox-active nanoceria in cancer therapeutics via oxidative stress. In Handbook of Oxidative Stress in Cancer: Therapeutic Aspects; Chakraborti, S., Ed.; Springer: Singapore, 2021; pp. 1–23. [Google Scholar]
- Rana, A.; Yadav, K.; Jagadevan, S. A comprehensive review on green synthesis of nature-inspired metal nanoparticles: Mechanism, application and toxicity. J. Clean. Prod. 2020, 272, 122880. [Google Scholar] [CrossRef]
- Rafique, M.; Sadaf, I.; Rafique, M.S.; Tahir, M.B. A review on green synthesis of silver nanoparticles and their applications. Artif. Cells Nanomed. Biotechnol. 2017, 45, 1272–1291. [Google Scholar] [CrossRef]
- Bandeira, M.; Giovanela, M.; Roesch-Ely, Μ.; Devine, D.M.; da Silva Crespo, J. Green synthesis of zinc oxide nanoparticles: A review of the synthesis methodology and mechanism of formation. Sustain. Chem. Pharm. 2020, 15, 100223. [Google Scholar] [CrossRef]
- Yildiz, Y.; Okyay, T.O.; Sen, B.; Gezer, B.; Kuzu, S.; Savk, A.; Demir, E.; Dasdelen, Z.; Sert, H.; Sen, F. Highly monodisperse Pt/Rh nanoparticles confined in the graphene oxide for highly efficient and reusable sorbents for methylene blue removal from aqueous solutions. ChemistrySelect 2017, 2, 697–701. [Google Scholar] [CrossRef]
- Göksu, H.; Çelik, B.; Yıldız, Y.; Şen, F.; Kılbaş, B. Superior monodisperse CNT-supported CoPd (CoPd@CNT) nanoparticles for selective reduction of nitro compounds to primary amines with NaBH4 in aqueous medium. ChemistrySelect 2016, 1, 2366–2372. [Google Scholar] [CrossRef]
- Sen, B.; Şavk, A.; Sen, F. Highly efficient monodisperse Pt nanoparticles confined in the carbon black hybrid material for hydrogen liberation. J. Colloid Interface Sci. 2018, 520, 112–118. [Google Scholar] [CrossRef]
- Şen, B.; Aygün, A.; Şavk, A.; Akocak, S.; Şen, F. Bimetallic palladium-iridium alloy nanoparticles as highly efficient and stable catalyst for the hydrogen evolution reaction. Int. J. Hydrogen Energy 2018, 43, 20183–20191. [Google Scholar] [CrossRef]
- Amina, M.; Al Musayeib, N.M.; Alarfaj, N.A.; El-Tohamy, M.F.; Oraby, H.F.; Al Hamoud, G.A.; Bukhari, S.I.; Moubayed, N.M.S. Biogenic green synthesis of MgO nanoparticles using Saussurea costus biomasses for a comprehensive detection of their antimicrobial, cytotoxicity against MCF-7 breast cancer cells and photocatalysis potentials. PLoS ONE 2020, 15, e0237567. [Google Scholar] [CrossRef]
- Danish, M.S.S.; Bhattacharya, A.; Stepanova, D.; Mikhaylov, A.; Grilli, M.L.; Khosravy, M.; Senjyu, T. A Systematic Review of Metal Oxide Applications for Energy and Environmental Sustainability. Metals 2020, 10, 1604. [Google Scholar] [CrossRef]
- Abdel-Aziz, M.M.; Emam, T.M.; Elsherbiny, E.A. Bioactivity of magnesium oxide nanoparticles synthesized from cell filtrate of endobacterium Burkholderia rinojensis against Fusarium oxysporum. Mater. Sci. Eng. C 2020, 109, 110617. [Google Scholar] [CrossRef]
- Aničić, N.; Vukomanović, M.; Koklič, T.; Suvorov, D. Fewer defects in the surface slows the hydrolysis rate, decreases the ROS generation potential, and improves the non-ROS antimicrobial activity of MgO. Small 2018, 14, 1800205. [Google Scholar] [CrossRef]
- Anand, K.V.; Anugraga, A.R.; Kannan, M.; Singaravelu, G.; Govindaraju, K. Bio-engineered magnesium oxide nanoparticles as nano-priming agent for enhancing seed germination and seedling vigour of green gram (Vigna radiata L.). Mater. Lett. 2020, 271, 127792. [Google Scholar] [CrossRef]
- Verma, S.K.; Nisha, K.; Panda, P.K.; Patel, P.; Kumari, P.; Mallick, M.A.; Sarkar, B.; Das, B. Green synthesized MgO nanoparticles infer biocompatibility by reducing in vivo molecular nanotoxicity in embryonic zebrafish through arginine interaction elicited apoptosis. Sci. Total Environ. 2020, 713, 136521. [Google Scholar] [CrossRef] [PubMed]
- Khan, A.; Shabir, D.; Ahmad, P.; Khandaker, M.U.; Faruque, M.R.I.; Din, I.U. Biosynthesis and antibacterial activity of MgO-NPs produced from Camellia-sinensis leaves extract. Mater. Res. Express 2020, 8, 15402. [Google Scholar] [CrossRef]
- Essien, E.R.; Atasie, V.N.; Okeafor, A.O.; Nwude, D.O. Biogenic synthesis of magnesium oxide nanoparticles using Manihot esculenta (Crantz) leaf extract. Int. Nano Lett. 2020, 10, 43–48. [Google Scholar] [CrossRef]
- Tang, Z.X.; Lv, B.F. MgO nanoparticles as antibacterial agent: Preparation and activity. Braz. J. Chem. Eng. 2014, 31, 591–601. [Google Scholar] [CrossRef]
- El-Sayyad, G.S.; Mosallam, F.M.; El-Batal, A.I. One-pot green synthesis of magnesium oxide nanoparticles using Penicillium chrysogenum melanin pigment and gamma rays with antimicrobial activity against multidrug-resistant microbes. Adv. Powder Technol. 2018, 29, 2616–2625. [Google Scholar] [CrossRef]
- Maji, J.; Pandey, S.; Basu, S. Synthesis and evaluation of antibacterial properties of magnesium oxide nanoparticles. Bull. Mater. Sci. 2020, 43, 25. [Google Scholar] [CrossRef]
- Castillo, I.F.; Guillén, E.G.; Jesús, M.; Silva, F.; Mitchell, S.G. Preventing fungal growth on heritage paper with antifungal and cellulase inhibiting magnesium oxide nanoparticles. J. Mater. Chem. B 2019, 7, 6412–6419. [Google Scholar] [CrossRef] [PubMed]
- Di, D.R.; He, Z.Z.; Sun, Z.Q.; Liu, J. A new nano-cryosurgical modality for tumor treatment using biodegradable MgO nanoparticles. Nanomedicine 2012, 8, 1233–1241. [Google Scholar] [CrossRef] [PubMed]
- Krishnamoorthy, K.; Moon, J.Y.; Hyun, H.B.; Cho, S.K.; Kim, S.J. Mechanistic investigation on the toxicity of MgO nanoparticles toward cancer cells. J. Mater. Chem. 2012, 22, 24610–24617. [Google Scholar] [CrossRef]
- Moeini-Nodeh, S.; Rahimifard, M.; Baeeri, M.; Abdollahi, M. Functional improvement in rats’ pancreatic islets using magnesium oxide nanoparticles through antiapoptotic and antioxidant pathways. Biol. Trace Elem. Res. 2017, 175, 146–155. [Google Scholar] [CrossRef] [PubMed]
- Derakhshankhah, H.; Nekounam, H.; Izadi, Z.; Allahyari, Z.; Samari, M.; Feizi, M.; Samadian, H. Fabrication of electroactive nanocomposite based on carbon nanofibers/magnesium oxide nanoparticles for bone tissue engineering. J. Drug Deliv. Sci. Technol. 2023, 89, 105082. [Google Scholar] [CrossRef]
- Liu, M.; Wang, R.; Liu, J.; Zhang, W.; Liu, Z.; Lou, X.; Nie, H.; Wang, H.; Mo, X.; Abd-Elhamid, A.I.; et al. Incorporation of magnesium oxide nanoparticles into electrospun membranes improves pro-angiogenic activity and promotes diabetic wound healing. Biomater. Adv. 2022, 133, 112609. [Google Scholar] [CrossRef]
- Li, J.; Khalid, A.; Verma, R.; Abraham, A.; Qazi, F.; Dong, X.; Liang, G.; Tomljenovic-Hanic, S. Silk Fibroin Coated Magnesium Oxide Nanospheres: A Biocompatible and Biodegradable Tool for Noninvasive Bioimaging Applications. Nanomaterials 2021, 11, 695. [Google Scholar] [CrossRef]
- El-Sawy, N.M.; Raafat, A.I.; Badawy, N.A.; Mohamed, A.M. Radiation development of pH-responsive (xanthan-acrylic acid)/MgO nanocomposite hydrogels for controlled delivery of methotrexate anticancer drug. Int. J. Biol. Macromol. 2020, 142, 254–264. [Google Scholar] [CrossRef]
- Manzetti, S.; Yakovlev, A. Quantum chemical study of regular and irregular geometries of MgO nanoclusters: Effects on magnetizability, electronic properties and physical characteristics. Mater. Chem. Phys. 2017, 199, 7–17. [Google Scholar] [CrossRef]
- Pacchioni, G.; Freund, H. Electron transfer at oxide surfaces. The MgO paradigm: From defects to ultrathin films. Chem. Rev. 2013, 113, 4035–4072. [Google Scholar] [CrossRef]
- Sternig, A.; Koller, D.; Siedl, N.; Diwald, O.; Mc Kenna, K. Exciton formation at solid-solid interfaces: A systematic experimental and ab Initio study on compressed MgO nanopowders. J. Phys. Chem. C 2012, 116, 10103–10112. [Google Scholar] [CrossRef]
- Bailly, M.L.; Costentin, G.; Pernot, H.L.; Krafft, J.M.; Che, M. Physicochemical and in-situ photoluminescence study of the reversible transformation of oxide ions of low coordination into hydroxyl groups upon interaction of water and methanol with MgO. J. Phys. Chem. B 2005, 169, 2404–2413. [Google Scholar] [CrossRef]
- Malykhin, S.E.; Volodin, A.M.; Bedilo, A.F.; Zhidomirov, G.F. Generation of O− radical anions on MgO surface: Long-distance charge separation or homolytic dissociation of chemisorbed water? J. Phys. Chem. C 2009, 113, 10350–10353. [Google Scholar] [CrossRef]
- Hemmingson, S.L.; Feeley, G.M.; Miyake, N.J.; Campbell, C.T. Energetics of 2D and 3D gold nanoparticles on MgO(100): Influence of particle size and defects on gold adsorption and adhesion energies. ACS Catal. 2017, 7, 2151–2163. [Google Scholar] [CrossRef]
- Petitjean, H.; Guesmi, H.; Lauron-Pernot, H.; Costentin, G.; Loffreda, D.; Sautet, P.; Delbecq, F. How surface hydroxyls enhance MgO reactivity in basic catalysis: The case of methylbutynol conversion. ACS Catal. 2014, 4, 4004–4014. [Google Scholar] [CrossRef]
- Singh, J.P.; Won, S.O.; Lim, W.C.; Chae, K.H. Optical behavior of MgO nanoparticles investigated using diffuse reflectance and near edge X-ray absorption spectroscopy. Mater. Lett. 2017, 198, 34–37. [Google Scholar] [CrossRef]
- Yin, D.; Chen, C.; Saito, M.; Inoue, K.; Ikuhara, Y. Ceramic phases with one-dimensional long-range order. Nat. Mater. 2019, 18, 19–23. [Google Scholar] [CrossRef]
- Müller, M.; Stankic, S.; Diwald, O.; Knözinger, O.; Sushko, P.V.; Trevisanutto, P.E.; Shluger, A.L. Effect of protons on the optical properties of oxide nanostructures. J. Am. Chem. Soc. 2007, 129, 12491–12496. [Google Scholar] [CrossRef]
- Subramanian, M.A.; Shannon, R.D.; Chai, B.H.T.; Abraham, M.M.; Wintersgill, M.C. Dielectric constants of BeO, MgO, and CaO using the two-terminal method. Phys. Chem. Miner. 1989, 16, 741–746. [Google Scholar] [CrossRef]
- Talukdar, T.K.; Liu, S.; Zhang, Z.; Harwath, F.; Girolami, G.S.; Abelson, J.R. Conformal MgO film grown at high rate at low temperature by forward-directed chemical vapor deposition. J. Vac. Sci. Technol. 2018, 36, 051504. [Google Scholar] [CrossRef]
- Thorp, J.S.; Enayati-Rad, N. The dielectric behaviour of single-crystal MgO, Fe/MgO and Cr/MgO. J. Math. Sci. 1981, 16, 255–260. [Google Scholar] [CrossRef]
- Liu, J.; Wang, W.; Guo, Z.; Zeng, W.R.; Dou, S.; Chen, X. Peashell-like nanostructure-a new kind of one-dimensional nanostructure: The case of magnesium oxide. Chem. Commun. 2010, 46, 3887–3889. [Google Scholar] [CrossRef] [PubMed]
- Hornak, J.; Trnka, P.; Kadlec, P.; Michal, O.; Mentlik, V.; Sutta, P.; Csanyi, G.M.; Tamus, Z.A. Magnesium oxide nanoparticles: Dielectric properties, surface functionalization and improvement of epoxy-based composites insulating properties. Nanomaterials 2018, 8, 381. [Google Scholar] [CrossRef] [PubMed]
- Bhargava, R.; Khan, S. Superior dielectric properties and bandgap modulation in hydrothermally grown Gr/MgO nanocomposite. Phys. Lett. 2019, 383, 1671–1676. [Google Scholar] [CrossRef]
- Wu, Y.Z.; Schmid, A.K.; Qiu, Z.Q. Spin-dependent quantum interference from epitaxial MgO thin films on Fe(001). Phys. Rev. Lett. 2006, 97, 217205. [Google Scholar] [CrossRef] [PubMed]
- Bertacco, R.; Ciccacci, F. Large spin asymmetry in electron absorption and reflection from oxidized single crystal Fe/MgO(001) films. Surf. Sci. 1999, 419, 265–271. [Google Scholar] [CrossRef]
- Loy, D.J.J.; Danajaya, P.A.; Hong, X.L.; Shum, D.P.; Lew, W.S. Conduction mechanisms on high retention annealed MgO-based resistive switching memory devices. Sci. Rep. 2018, 8, 14774. [Google Scholar] [CrossRef] [PubMed]
- Guo, Y.; Song, Q.; Yan, H. The influence of interaction between oxygen vacancies on set process in resistive switching: A case of MgO. AIP Adv. 2019, 5, 055230. [Google Scholar] [CrossRef]
- Jambois, O.; Carreras, P.; Antony, A.; Bertomeu, J.; Martínez-Boubeta, C. Resistance switching in transparent magnetic MgO films. Solid State Commun. 2011, 151, 1856–1859. [Google Scholar] [CrossRef]
- Dias, C.; Guerra, L.M.; Bordalo, B.D.; Lv, H.; Ferraria, A.M.; do Rego, A.M.B.; Cardoso, S.; Freitas, P.P.; Ventura, J. Voltage-polarity dependent multi-mode resistive switching on sputtered MgO nanostructures. Phys. Chem. Chem. Phys. 2017, 19, 10898–10904. [Google Scholar] [CrossRef] [PubMed]
- Uchino, T.; Okutsu, D. Broadband laser emission from color centers inside MgO microcrystals. Phys. Rev. Lett. 2008, 101, 117401–117404. [Google Scholar] [CrossRef] [PubMed]
- Uchino, T.; Okutsu, D.; Katayama, R.; Sawai, S. Mechanism of stimulated optical emission from MgO microcrystals with color centers. Phys. Rev. B 2009, 79, 165107. [Google Scholar] [CrossRef]
- Kumar, A.; Thota, S.; Verma, S.; Kumar, J. Sol-gel synthesis of highly luminescent magnesium oxide nanocrystallites. J. Lumin. 2011, 131, 640–648. [Google Scholar] [CrossRef]
- Debaraja, P.B.; Abadhani, D.N.; Prashantha, S.C.; Nagabhushana, H.; Sharma, S.C.; Nagabhushan, B.M.; Nagaswarup, H.P. Synthesis, structural and luminescence studies of magnesium oxide nanopowder. Spectrochim. Acta Mol. Biomol. Spect. 2014, 118, 847–851. [Google Scholar] [CrossRef]
- Chaudhri, M.M.; Sands, H.S. Photoluminescence from indented MgO crystals using a near ultraviolet/visible Raman microscope. J. Appl. Phys. 1997, 82, 785–791. [Google Scholar] [CrossRef]
- Halder, R.; Bandyopadhyay, S. Spark plasma sintering of nano magnesia: Processing parameters influencing optical properties. Mater. Chem. Phys. 2019, 228, 51–59. [Google Scholar] [CrossRef]
- Benia, H.M.; Lin, X.; Gao, H.-J.; Nilius, N.; Freund, H.-J. Nucleation and growth of gold on MgO thin films: A combined STM and luminescence study. J. Phys. Chem. C 2007, 111, 10528–10533. [Google Scholar] [CrossRef]
- Skvortsova, V.; Trinkler, L. Luminescence of impurities and radiation defects in magnesium oxide irradiated by fast neutrons. Phys. Procedia 2009, 2, 567–570. [Google Scholar] [CrossRef]
- Abramishvili, M.; Akhvlediani, Z.; Galustashvili, M.; Dekanozishvili, G.; Kalabegishvili, T.; Kvatchadze, V.; Tavkhelidze, V. Peculiarities of radiation effects in MgO: Mn2+ crystals. J. Mod. Phys. 2011, 2, 841–844. [Google Scholar] [CrossRef]
- Pathak, N.; Gupta, S.K.; Prajapat, C.L.; Sharma, S.K.; Ghosh, P.S.; Kanrar, B.; Pujari, P.K.; Kadam, R.M. Defect-induced ferromagnetism in MgO and its exceptional enhancement upon thermal annealing: A case of transformation of various defect states. Phys. Chem. Chem. Phys. 2017, 19, 11975–11989. [Google Scholar] [CrossRef]
- Jain, N.; Marwaha, N.; Verma, R.; Gupta, B.K.; Srivastava, A.K. Facile synthesis of defect-induced highly-luminescent pristine MgO nanostructures for promising solid-state lighting applications. RSC Adv. 2016, 6, 4960–4968. [Google Scholar] [CrossRef]
- Siedl, N.; Koller, D.; Sternig, A.K.; Thomelea, D.; Diwald, O. Photoluminescence quenching in compressed MgO nanoparticle systems. Phys. Chem. Chem. Phys. 2014, 16, 8339–8345. [Google Scholar] [CrossRef]
- Cao, X.; Dai, H.; Chen, S.; Zeng, J.; Zhang, K.; Sun, Y. A high selective cataluminescence sensor for the determination of tetrahydrofuran vapor. Meas. Sci. Technol. 2013, 24, 025103. [Google Scholar] [CrossRef]
- Chu, Y.; Zhang, Q.; Zhang, W.; Zhang, G.; Zhu, S. Highly sensitive dimethyl ether gas sensor utilizing cataluminescence on nanosized MgO/In2O3. Meas. Sci. Technol. 2014, 25, 085105. [Google Scholar] [CrossRef]
- Ngo, C.; Voorde, M. Nanotechnology in a Nutshell: From Simple to Complex Systems; Atlantis Press: Paris, France, 2014. [Google Scholar]
- Baraket, L.; Ghorbel, A. Control preparation of aluminium chromium mixed oxides by Sol-Gel process. In Studies in Surface Science and Catalysis; Delmon, B., Jacobs, P.A., Maggi, R., Martens, J.A., Grange, P., Poncelet, G., Eds.; Preparation of Catalysts VII; Elsevier: Amsterdam, The Netherlands, 1998; Volume 118, pp. 657–667. [Google Scholar]
- Feng, S.H.; Li, G.H. Chapter 4-Hydrothermal and Solvothermal Syntheses. In Modern Inorganic Synthetic Chemistry, 2nd ed.; Xu, R., Xu, Y., Eds.; Elsevier: Amsterdam, The Netherlands, 2017; pp. 73–104. [Google Scholar]
- Yeh, C.L. Combustion Synthesis: Principles and Applications. In Reference Module in Materials Science and Materials Engineering; Elsevier: Amsterdam, The Netherlands, 2016. [Google Scholar]
- Rane, A.V.; Kanny, K.; Abitha, V.K.; Thomas, S. Methods for Synthesis of Nanoparticles and Fabrication of Nanocomposites. In Synthesis of Inorganic Nanomaterials; Mohan Bhagyaraj, S., Oluwafemi, O.S., Kalarikkal, N., Thomas, S., Eds.; Micro and Nano Technologies; Woodhead Publishing: Cambridge, UK, 2018; pp. 121–139. [Google Scholar]
- Pal, G.; Rai, P.; Pandey, A. Green synthesis of nanoparticles: A greener approach for a cleaner future. In Green Synthesis, Characterization and Applications of Nanoparticles; Shukla, A.K., Iravani, S., Eds.; Micro and Nano Technologies; Elsevier: Amsterdam, The Netherlands, 2019; pp. 1–26. [Google Scholar]
- Sutapa, I.W.; Wahab, A.W.; Taba, P.; Nafie, N.L. Synthesis and structural profile analysis of the MgO nanoparticles produced through the sol-gel method followed by annealing process. Orient. J. Chem. 2018, 34, 1016–1025. [Google Scholar] [CrossRef]
- Escudero, A.; Carrillo-Carrión, C.; Romero-Ben, E.; Franco, A.; Rosales-Barrios, C.; Castillejos, M.C.; Khiar, N. Molecular Bottom-Up Approaches for the Synthesis of Inorganic and Hybrid Nanostructures. Inorganics 2021, 9, 58. [Google Scholar] [CrossRef]
- Burlakov, V.M.; Goriely, A. Reverse Coarsening and the Control of Particle Size Distribution through Surfactant. Appl. Sci. 2020, 10, 5359. [Google Scholar] [CrossRef]
- Antúnez-García, J.; Mejía-Rosales, S.; Pérez-Tijerina, E.; Montejano-Carrizales, J.M.; José-Yacamán, M. Coalescence and Collisions of Gold Nanoparticles. Materials 2011, 4, 368–379. [Google Scholar] [CrossRef]
- Hornak, J. Synthesis, properties, and selected technical applications of magnesium oxide nanoparticles: A review. Int. J. Mol. Sci. 2021, 22, 12752. [Google Scholar] [CrossRef]
- Lai, Y.F.; Chaudouët, P.; Charlot, F.; Matko, I.; Dubourdieu, C. Magnesium oxide nanowires synthesized by pulsed liquid-injection metal organic chemical vapor deposition. Appl. Phys. Lett. 2009, 94, 022904. [Google Scholar] [CrossRef]
- Sirota, V.; Selemenev, V.; Kovaleva, M.; Pavlenko, I.; Mamunin, K.; Dokalov, V.; Prozorova, M. Synthesis of magnesium oxide nanopowder by thermal plasma using magnesium nitrate hexahydrate. Phys. Res. Inter. 2016, 4, 6853405. [Google Scholar] [CrossRef]
- Gandhi, S.; Abiramipriya, P.; Pooja, N.; Jeyakumari, J.J.L.; Arasi, A.Y.; Dhanalakshmi, V.; Gopinathan, M.R.; Anbarasan, R. Synthesis and characterizations of nano-sized MgO and its nano composite with poly(vinyl alcohol). J. Non-Cryst. Solids 2011, 357, 181–185. [Google Scholar] [CrossRef]
- Karthik, K.; Dhanuskodi, S.; Gobinath, C.; Prabukumar, S.; Sivaramakrishnan, S. Fabrication of MgO nanostructures and its efficient photocatalytic, antibacterial and anticancer performance. J. Photochem. Photobiol. B 2019, 190, 8–20. [Google Scholar] [CrossRef]
- Supin, K.K.; Saji, A.; Chanda, A.; Vasundhara, M. Effects of calcinations temperatures on structural, optical and magnetic properties of MgO nanoflakes and its photocatalytic applications. Opt. Mater. 2022, 132, 112777. [Google Scholar] [CrossRef]
- Al-Hazmi, F.; Alnowaiser, F.; Al-Ghamdi, A.A.; Al-Ghamdi, A.A.; Aly, M.M.; Al-Tuwirqi, R.M.; El-Tantawy, F. A New large-scale synthesis of magnesium oxide nanowires: Structural and antibacterial properties. Superlattices Microstruct. 2012, 52, 200–209. [Google Scholar] [CrossRef] [PubMed]
- Ullah, H.; Ahmad, R.; Khan, A.A.; Khaliq, N.; Khan, M.; Ali, G.; Karim, S.; Yi, X.; Cho, S.O. A sensitive non-enzymatic glucose sensor based on MgO entangled nanosheets decorated with CdS nanoparticles: Experimental and DFT study. J. Mol. Liq. 2022, 360, 119366. [Google Scholar] [CrossRef]
- Mantzaris, N.V. Liquid-Phase Synthesis of Nanoparticles: Particle Size Distribution Dynamics and Control. Chem. Eng. Sci. 2005, 60, 4749–4770. [Google Scholar] [CrossRef]
- Swihart, M.T. Vapor-Phase Synthesis of Nanoparticles. Curr. Opin. Colloid Interface Sci. 2003, 8, 127–133. [Google Scholar] [CrossRef]
- Benrabaa, R.; Boukhlouf, H.; Bordes-Richard, E.; Vannier, R.N.; Barama, A. Nanosized nickel ferrite catalysts for CO2 reforming of methane at low temperature: Effect of preparation method and acid-base properties. In Studies in Surface Science and Catalysis; Gaigneaux, E.M., Devillers, M., Hermans, S., Jacobs, P.A., Martens, J.A., Ruiz, P., Eds.; Scientific Bases for the Preparation of Heterogeneous Catalysts; Elsevier: Amsterdam, The Netherlands, 2010; Volume 175, pp. 301–304. [Google Scholar]
- Huang, G.; Lu, C.H.; Yang, H.H. Magnetic Nanomaterials for Magnetic Bioanalysis. In Novel Nanomaterials for Biomedical, Environmental and Energy Applications; Wang, X., Chen, X., Eds.; Micro and Nano Technologies; Elsevier: Amsterdam, The Netherlands, 2019; pp. 89–109. [Google Scholar]
- Rashid, H.; Manson, A.M.; Haider, B.; Nasir, R.; Hamid, S.B.A.; Abdulrahman, A. Synthesis and Characterization of Magnetite Nanoparticles with High Selectivity Using In-Situ Precipitation Method. Sep. Sci. Technol. 2020, 6, 1207–1215. [Google Scholar] [CrossRef]
- Tartaj, P.; del Puerto Morales, M.; Veintemillas-Verdaguer, S.; González-Carreño, T.; Serna, C.J. The Preparation of Magnetic Nanoparticles for Applications in Biomedicine. J. Phys. D Appl. Phys. 2003, 36, 182–197. [Google Scholar] [CrossRef]
- Kumar, R.; Sharma, A.; Kishore, N. Preparation and Characterization of MgO Nanoparticles by Co-Precipitation Method. Int. J. Phys. 2013, 6, 66–70. [Google Scholar]
- Karthikeyan, V.; Dhanapandian, S.; Manoharan, C. Characterization and Antibacterial Behavior of MgO-PEG Nanoparticles Synthesized via Co-Precipitation Method. Int. Lett. Chem. Phys. Astron. 2016, 70, 33–41. [Google Scholar] [CrossRef]
- Tandon, M.; Chauhan, P. Surfactant Free Synthesis of Magnesium Oxide Nanotubes by Simple Chemical Co-Precipitation Method. Int. J. Innov. Technol. Explor. Eng. 2020, 9, 2504–2506. [Google Scholar] [CrossRef]
- Yadav, P.; Saini, R.; Bhaduri, A. Facile synthesis of MgO nanoparticles for effective degradation of organic dyes. Environ. Sci. Pollut. Res. Int. 2023, 30, 71439–71453. [Google Scholar] [CrossRef]
- Soytaş, S.H.; Oğuz, O.; Menceloğlu, Y.Z. Polymer Nanocomposites With Decorated Metal Oxides. In Polymer Composites with Functionalized Nanoparticles; Pielichowski, K., Majka, T.M., Eds.; Micro and Nano Technologies; Elsevier: Amsterdam, The Netherlands, 2019; pp. 287–323. [Google Scholar]
- Sham, E.L.; Murgia, V.; Gottifredi, J.C.; Farfán-Torres, E.M. V2O5-SiO2 Catalyst Prepared by the sol-gel Process in the Oxidative Dehydrogenation of n-butane. In Studies in Surface Science and Catalysis; Delmon, B., Jacobs, P.A., Maggi, R., Martens, J.A., Grange, P., Poncelet, G., Eds.; Preparation of Catalysts VII; Elsevier: Amsterdam, The Netherlands, 1998; Volume 118, pp. 669–678. [Google Scholar]
- Sutapa, I.W.; Wahab, A.W.; Taba, P.; Nafie, N.L. Dislocation, Crystallite Size Distribution and Lattice Strain of Magnesium Oxide Nanoparticles. J. Phys. Conf. Ser. 2018, 979, 012021. [Google Scholar] [CrossRef]
- Wahab, R.; Ansari, S.G.; Dar, M.A.; Kim, Y.S.; Shin, H.S. Synthesis of Magnesium Oxide Nanoparticles by Sol-Gel Process. Mater. Sci. Forum 2007, 558–559, 983–986. [Google Scholar] [CrossRef]
- Boddu, V.M.; Viswanath, D.S.; Maloney, S.W. Synthesis and Characterization of Coralline Magnesium Oxide Nanoparticles. J. Am. Ceram. Soc. 2008, 91, 1718–1720. [Google Scholar] [CrossRef]
- Dercz, G.; Prusik, K.; Pajak, L.; Pielaszek, R.; Malinowski, J.J.; Pudło, W. Structure Studies on Nanocrystalline Powder of MgO Xerogel Prepared by the Sol-Gel Method. Mater. Sci. 2009, 27, 201–207. [Google Scholar] [CrossRef]
- Nassar, M.Y.; Mohamed, T.Y.; Ahmed, I.S.; Samir, I. MgO Nanostructure via a Sol-Gel Combustion Synthesis Method Using Different Fuels: An Efficient Nano-Adsorbent for the Removal of Some Anionic Textile Dyes. J. Mol. Liq. 2017, 225, 730–740. [Google Scholar] [CrossRef]
- Ng, J.J.; Leong, K.H.; Sim, L.C.; Oh, W.-D.; Dai, C.; Saravanan, P. Environmental remediation using nano-photocatalyst under visible light irradiation: The case of bismuth phosphate. In Nanomaterials for Air Remediation; Abdeltif, A., Assadi, A.A., Nguyen-Tri, P., Nguyen, T.A., Rtimi, S., Eds.; Micro and Nano Technologies; Elsevier: Amsterdam, The Netherlands, 2020; pp. 193–207. [Google Scholar]
- Williams, M.J.; Corr, S.A. Magnetic Nanoparticles for Targeted Cancer Diagnosis and Therapy. In Frontiers of Nanoscience; Summers, H., Ed.; Nanomedicine; Elsevier: Amsterdam, The Netherlands, 2013; Volume 5, pp. 29–63. [Google Scholar]
- Ding, Y.; Zhang, G.; Wu, H.; Hai, B.; Wang, L.; Qian, Y. Nanoscale Magnesium Hydroxide and Magnesium Oxide Powders: Control over Size, Shape, and Structure via Hydrothermal Synthesis. Chem. Mater. 2001, 13, 435–440. [Google Scholar] [CrossRef]
- Rukh, S.; Sofi, A.H.; Shah, M.A.; Yousuf, S. Antibacterial Activity of Magnesium Oxide Nanostructures Prepared by Hydrothermal Method. Asian J. Nanosci. Mater. 1999, 2, 425–430. [Google Scholar] [CrossRef]
- Varma, A.V.; Mukasyan, A.S.; Rogachev, A.S.; Manukyan, K.V. Solution Combustion Synthesis of Nanoscale Materials. Chem. Rev. 2016, 116, 14493–14586. [Google Scholar] [CrossRef] [PubMed]
- Mukasyan, A.S.; Manukyan, K.V. One- and Two-Dimensional Nanostructures Prepared by Combustion Synthesis. In Nanomaterials Synthesis; Beeran Pottathara, Y., Thomas, S., Kalarikkal, N., Grohens, Y., Kokol, V., Eds.; Micro and Nano Technologies; Elsevier: Amsterdam, The Netherlands, 2019; pp. 85–120. [Google Scholar]
- Stojanovic, B.D.; Dzunuzovic, A.S.; Ilic, N.I. Review of methods for the preparation of magnetic metal oxides. In Magnetic, Ferroelectric, and Multiferroic Metal Oxides; Stojanovic, B.D., Ed.; Metal Oxides; Elsevier: Amsterdam, The Netherlands, 2018; pp. 333–359. [Google Scholar]
- Mukasyan, A.S.; Dinka, P. Novel Approaches to Solution-Combustion Synthesis of Nanomaterials. Int. J. Self-Propag. High-Temp. Synth. 2007, 16, 23–35. [Google Scholar] [CrossRef]
- Balakrishnan, G.; Velavan, R.; Mujasam Batoo, K.; Raslan, E.H. Microstructure, Optical and Photocatalytic Properties of MgO Nanoparticles. Results Phys. 2020, 16, 103013. [Google Scholar] [CrossRef]
- Rao, K.V.; Sunandana, C.S. Structure and Microstructure of Combustion Synthesized MgO Nanoparticles and Nanocrystalline MgO Thin Films Synthesized by Solution Growth Route. J. Mater. Sci. 2008, 43, 146–154. [Google Scholar] [CrossRef]
- Tharani, K.; Jegatha Christy, A.; Sagadevan, S.; Nehru, L.C. Fabrication of Magnesium Oxide Nanoparticles Using Combustion Method for a Biological and Environmental Cause. Chem. Phys. Lett. 2021, 763, 138216. [Google Scholar] [CrossRef]
- Kumar, D.; Yadav, L.S.R.; Lingaraju, K.; Manjunath, K.; Suresh, D.; Prasad, D.; Nagabhushana, H.; Sharma, S.C.; Naika, H.R.; Chikkahanumantharayappa; et al. Combustion Synthesis of MgO Nanoparticles Using Plant Extract: Structural Characterization and Photoluminescence Studies. AIP Conf. Proc. 2015, 1665, 050145. [Google Scholar] [CrossRef]
- Devatha, C.P.; Thalla, A.K. Green Synthesis of Nanomaterials. In Synthesis of Inorganic Nanomaterials; Mohan Bhagyaraj, S., Oluwafemi, O.S., Kalarikkal, N., Thomas, S., Eds.; Micro and Nano Technologies; Woodhead Publishing: Cambridge, UK, 2018; pp. 169–184. [Google Scholar]
- Verma, R.; Pathak, S.; Srivastava, A.K.; Prawer, S.; Tomljenovic-Hanic, S. ZnO Nanomaterials: Green Synthesis, Toxicity Evaluation and New Insights in Biomedical Applications. J. Alloy Compd. 2021, 876, 160175. [Google Scholar] [CrossRef]
- Zhu, X.; Pathakoti, K.; Hwang, H.-M. Green synthesis of titanium dioxide and zinc oxide nanoparticles and their usage for antimicrobial applications and environmental remediation. In Green Synthesis, Characterization and Applications of Nanoparticles; Shukla, A.K., Iravani, S., Eds.; Micro and Nano Technologies; Elsevier: Amsterdam, The Netherlands, 2019; pp. 223–263. [Google Scholar]
- Akhtar, M.S.; Panwar, J.; Yun, Y.-S. Biogenic synthesis of metallic nanoparticles by plant extracts. ACS Sustain. Chem. Eng. 2013, 1, 591–602. [Google Scholar] [CrossRef]
- Demirbas, A.; Welt, B.A.; Ocsoy, I. Biosynthesis of red cabbage extract directed Ag NPs and their effect on the loss of antioxidant activity. Mater. Lett. 2016, 179, 20–23. [Google Scholar] [CrossRef]
- Ocsoy, I.; Tasdemir, D.; Mazicioglu, S.; Celik, C.; Katı, A.; Ulgen, F. Biomolecules incorporated metallic nanoparticles synthesis and their biomedical applications. Mater. Lett. 2018, 212, 45–50. [Google Scholar] [CrossRef]
- Aygün, A.; Gülbağça, F.; Nas, M.S.; Alma, M.H.; Çalımlı, M.H.; Ustaoglu, B.; Altunoglu, Y.C.; Baloğlu, M.C.; Cellat, K.; Şen, F. Biological synthesis of silver nanoparticles using Rheum ribes and evaluation of their anticarcinogenic and antimicrobial potential: A novel approach in phytonanotechnology. J. Pharm. Bomed. Anal. 2020, 179, 113012. [Google Scholar] [CrossRef] [PubMed]
- Demirbas, A.; Yilmaz, V.; Ildiz, N.; Baldemir, A.; Ocsoy, I. Anthocyanins-rich berry extracts directed formation of Ag NPs with the investigation of their antioxidant and antimicrobial activities. J. Mol. Liq. 2017, 248, 1044–1049. [Google Scholar] [CrossRef]
- Altinsoy, B.D.; Karatoprak, G.Ş.; Ocsoy, I. Extracellular directed Ag NPs formation and investigation of their antimicrobial and cytotoxic properties. Saudi Pharm. J. 2019, 27, 9–16. [Google Scholar] [CrossRef]
- Singh, J.; Dutta, T.; Kim, K.-H.; Rawat, M.; Samddar, P.; Kumar, P. Green synthesis of metals and their oxide nanoparticles: Applications for environmental remediation. J. Nanobiotechnol. 2018, 16, 84. [Google Scholar] [CrossRef] [PubMed]
- Praveen Kumar, P.; Laxmi Deepak Bhatlu, M.; Sukanya, K.; Karthikeyan, S.; Jayan, N. Synthesis of Magnesium Oxide Nanoparticle by Eco-Friendly Method (Green Synthesis)-A Review. Mater. Today Proc. 2021, 37, 3028–3030. [Google Scholar] [CrossRef]
- Shah, M.; Fawcett, D.; Sharma, S.; Tripathy, S.K.; Poinern, G.E.J. Green synthesis of metallic nanoparticles via biological entities. Materials 2015, 8, 7278–7308. [Google Scholar] [CrossRef]
- Dauthal, P.; Mukhopadhyay, M. Noble metal nanoparticles: Plant-mediated synthesis, mechanistic aspects of synthesis, and applications. Ind. Eng. Chem. Res. 2016, 55, 9557–9577. [Google Scholar] [CrossRef]
- El Shafey, A.M. Green synthesis of metal and metal oxide nanoparticles from plant leaf extracts and their applications: A review. Green Process. Synth. 2020, 9, 304–339. [Google Scholar] [CrossRef]
- Akintelu, S.A.; Folorunso, A.S. A review on green synthesis of zinc oxide nanoparticles using plant extracts and its biomedical applications. Bionanoscience 2020, 10, 848–863. [Google Scholar] [CrossRef]
- Karmous, I.; Pandey, A.; Ben Haj, K.; Chaoui, A. Efficiency of the green synthesized nanoparticles as new tools in cancer therapy: Insights on plant-based bioengineered nanoparticles, biophysical properties, and anticancer roles. Biol. Trace Elem. Res. 2019, 196, 330–342. [Google Scholar] [CrossRef]
- Jeevanandam, J.; Chan, Y.S.; Danquah, M.K. Biosynthesis of metal and metal oxide nanoparticles. ChemBioEng Rev. 2016, 3, 55–67. [Google Scholar] [CrossRef]
- Joghee, S.; Ganeshan, P.; Vincent, A.; Hong, S.I. Ecofriendly biosynthesis of zinc oxide and magnesium oxide particles from medicinal plant Pisonia grandis R. Br. leaf extract and their antimicrobial activity. Bionanoscience 2019, 9, 141–154. [Google Scholar] [CrossRef]
- Suresh, J.; Yuvakkumar, R.; Sundrarajan, M.; Hong, S.I. Green Synthesis of Magnesium Oxide Nanoparticles. Adv. Mater. Res. 2014, 952, 141–144. [Google Scholar] [CrossRef]
- Younis, I.Y.; El-Hawary, S.S.; Eldahshan, O.A.; Abdel-Aziz, M.M.; Ali, Z.Y. Green Synthesis of Magnesium Nanoparticles Mediated from Rosa Floribunda Charisma Extract and Its Antioxidant, Antiaging and Antibiofilm Activities. Sci. Rep. 2021, 11, 16868. [Google Scholar] [CrossRef]
- Abdallah, Y.; Ogunyemi, S.O.; Abdelazez, A.; Zhang, M.; Hong, X.; Ibrahim, E.; Hossain, A.; Fouad, H.; Li, B.; Chen, J. The Green Synthesis of MgO Nano-Flowers Using Rosmarinus officinalis L. (Rosemary) and the Antibacterial Activities against Xanthomonas oryzae pv. oryzae. BioMed Res. Int. 2019, 2019, 5620989. [Google Scholar] [CrossRef] [PubMed]
- Sharma, G.; Soni, R.; Jasuja, N.D. Phytoassisted Synthesis of Magnesium Oxide Nanoparticles with Swertia Chirayaita. J. Taibah Univ. Sci. 2017, 11, 471–477. [Google Scholar] [CrossRef]
- Fatiqin, A.; Amrulloh, H.; Simanjuntak, W. Green Synthesis of MgO Nanoparticles Using Moringa Oleifera Leaf Aqueous Extract for Antibacterial Activity. Bull. Chem. Soc. Ethiop. 2021, 35, 161–170. [Google Scholar] [CrossRef]
- Singh, A.; Joshi, N.C.; Ramola, M. Magnesium oxide nanoparticles (MgONPs): Green synthesis, characterizations and antimicrobial activity. Res. J. Pharm. Technol. 2019, 12, 4644–4646. [Google Scholar] [CrossRef]
- Sneha, K.; Sathishkumar, M.; Mao, J.; Kwak, I.S.; Yun, Y.-S. Corynebacterium glutamicum-mediated crystallization of silver ions through sorption and reduction processes. Chem. Eng. J. 2010, 162, 989–996. [Google Scholar] [CrossRef]
- Gowramma, B.; Keerthi, U.; Rafi, M.; Rao, D.M. Biogenic silver nanoparticles production and characterization from native strain of Corynebacterium species and its antimicrobial activity. 3 Biotech 2015, 5, 195–201. [Google Scholar] [CrossRef]
- Wang, H.; Chen, H.; Wang, Y.; Huang, J.; Kong, T.; Lin, W.; Zhou, Y.; Lin, L.; Sun, D.; Li, Q. Stable silver nanoparticles with narrow size distribution non-enzymatically synthesized by Aeromonas sp. SH10 cells in the presence of hydroxyl ions. Curr. Nanosci. 2012, 8, 838–846. [Google Scholar] [CrossRef]
- Narendhran, S.; Manikandan, M.; Shakila, P.B. Antibacterial, antioxidant properties of Solanum trilobatum and sodium hydroxide-mediated magnesium oxide nanoparticles: A green chemistry approach. Bull. Mater. Sci. 2019, 42, 133. [Google Scholar] [CrossRef]
- Ogunyemi, S.O.; Zhang, F.; Abdallah, Y.; Zhang, M.; Wang, Y.; Sun, G.; Qiu, W.; Li, B. Biosynthesis and characterization of magnesium oxide and manganese dioxide nanoparticles using Matricaria chamomilla L. extract and its inhibitory effect on Acidovorax oryzae strain RS-2. Artif. Cells Nanomed. Biotechnol. 2019, 47, 2230–2239. [Google Scholar] [CrossRef]
- Pugazhendhi, A.; Prabhu, R.; Muruganantham, K.; Shanmuganathan, R.; Natarajan, S. Anticancer, antimicrobial and photocatalytic activities of green synthesized magnesium oxide nanoparticles (MgONPs) using aqueous extract of Sargassum wightii. J. Photochem. Photobiol. B 2019, 190, 86–97. [Google Scholar] [CrossRef]
- Mohanasrinivasan, V.; Subathra Devi, C.; Mehra, A.; Prakash, S.; Agarwal, A.; Selvarajan, E.; Jemimah Naine, S. Biosynthesis of MgO nanoparticles using Lactobacillus sp. and its activity against human leukemia cell lines HL-60. BioNanoScience 2018, 8, 249–253. [Google Scholar] [CrossRef]
- Ibrahem, E.J.; Thalij, K.M.; Badawy, A.S. Antibacterial Potential of Magnesium Oxide Nanoparticles Synthesized by Aspergillus niger. Biotechnol. J. Int. 2017, 18, 1–7. [Google Scholar] [CrossRef]
- Sagar, S.; Kaistha, S.; Das, A.J.; Kumar, R. Bacteriophage: A new hope for the control of antibiotic-resistant bacteria. In Antibiotic Resistant Bacteria: A Challenge to Modern Medicine; Springer: Singapore, 2019; pp. 153–164. [Google Scholar]
- Das, B.; Moumita, S.; Ghosh, S.; Khan, M.I.; Indira, D.; Jayabalan, R.; Tripathy, S.K.; Mishra, A.; Balasubramanian, P. Biosynthesis of magnesium oxide (MgO) nanoflakes by using leaf extract of Bauhinia purpurea and evaluation of its antibacterial property against Staphylococcus aureus. Mater. Sci. Eng. C 2018, 91, 436–444. [Google Scholar] [CrossRef]
- Ananda, A.; Ramakrishnappa, T.; Archana, S.; Reddy Yadav, L.S.; Shilpa, B.M.; Nagaraju, G.; Jayanna, B.K. Green synthesis of MgO nanoparticles using Phyllanthus emblica for Evans blue degradation and antibacterial activity. Mater. Today Proc. 2021, 49, 801–810. [Google Scholar] [CrossRef]
- Sharma, S.K.; Khan, A.U.; Khan, M.; Gupta, M.; Gehlot, A.; Park, S.; Alam, M. Biosynthesis of MgO nanoparticles using Annona squamosa seeds and its catalytic activity and antibacterial screening. Micro Nano Lett. 2020, 15, 30–34. [Google Scholar] [CrossRef]
- Cai, L.; Chen, J.; Liu, Z.; Wang, H.; Yang, H.; Ding, W. Magnesium oxide nanoparticles: Effective agricultural antibacterial agent against Ralstonia solanacearum. Front. Microbiol. 2018, 9, 790. [Google Scholar] [CrossRef]
- Makhluf, S.; Dror, R.; Nitzan, Y.; Abramovich, Y.; Jelinek, R.; Gedanken, A. Microwave-assisted synthesis of nanocrystalline MgO and its use as a bacteriocide. Adv. Funct. Mater. 2005, 15, 1708–1715. [Google Scholar] [CrossRef]
- Huang, L.; Li, D.; Lin, Y.; Evans, D.G.; Duan, X. Influence of nano-MgO particle size on bactericidal action against Bacillus subtilis var. niger. Chin. Sci. Bull. 2005, 50, 514–519. [Google Scholar] [CrossRef]
- Bindhu, M.; Umadevi, M.; Micheal, M.K.; Arasu, M.V.; Al-Dhabi, N.A. Structural, morphological and optical properties of MgO nanoparticles for antibacterial applications. Mater. Lett. 2016, 166, 19–22. [Google Scholar] [CrossRef]
- Sawai, J.; Kojima, H.; Igarashi, H.; Hashimoto, A.; Shoji, S.; Sawaki, T.; Hakoda, A.; Kawada, E.; Kokugan, T.; Shimizu, M. Antibacterial characteristics of magnesium oxide powder. World J. Microbiol. Biotechnol. 2000, 16, 187–194. [Google Scholar] [CrossRef]
- Krishnamoorthy, K.; Manivannan, G.; Kim, S.J.; Jeyasubramanian, K.; Premanathan, M. Antibacterial activity of MgO nanoparticles based on lipid peroxidation by oxygen vacancy. J. Nanopart. Res. 2012, 14, 1063. [Google Scholar] [CrossRef]
- Suresh, J.; Pradheesh, G.; Alexramani, V.; Sundrarajan, M.; Hong, S.I. Green synthesis and characterization of hexagonal shaped MgO nanoparticles using insulin plant (Costus pictus D. Don) leave extract and its antimicrobial as well as anticancer activity. Adv. Powder Technol. 2018, 29, 1685–1694. [Google Scholar] [CrossRef]
- Kainat, M.A.; Khan, F.; Ali, S.; Faisal, M.; Rizwan, M.; Hussain, Z.; Zaman, N.; Afsheen, Z.; Uddin, M.N.; Bibi, N. Exploring the therapeutic potential of Hibiscus rosa sinensis synthesized cobalt oxide (Co3O4-NPs) and magnesium oxide nanoparticles (MgO-NPs). Saudi J. Biol. Sci. 2021, 28, 5157–5167. [Google Scholar] [CrossRef]
- Amrulloh, H.; Fatiqin, A.; Simanjuntak, W.; Afriyani, H.; Annissa, A. Antioxidant and antibacterial activities of magnesium oxide nanoparticles prepared using aqueous extract of Moringa oleifera bark as green agents. J. Multidiscip. Appl. Nat. Sci. 2021, 1, 44–53. [Google Scholar] [CrossRef]
- Nejati, M.; Rostami, M.; Mirzaei, H.; Rahimi-Nasrabadi, M.; Vosoughifar, M.; Sobhani Nasab, A.; Ganjali, M.R. Green methods for the preparation of MgO nanomaterials and their drug delivery, anti-cancer and anti-bacterial potentials: A review. Inorg. Chem. Commun. 2022, 136, 109107. [Google Scholar] [CrossRef]
- Rodrigues, M.L.; Nosanchuk, J.D. Fungal diseases as neglected pathogens: A wake-up call to public health officials. PLoS Negl. Trop. Dis. 2020, 14, e0007964. [Google Scholar] [CrossRef]
- Sierra-Fernandez, A.; De la Rosa-García, S.C.; Gomez-Villalba, L.S.; Gomez-Cornelio, S.; Rabanal, M.E.; Fort, R.; Quintana, P. Synthesis, photocatalytic, and antifungal properties of MgO, ZnO, and Zn/Mg oxide nanoparticles for the protection of calcareous stone heritage. ACS Appl. Mater. Interfaces 2017, 9, 24873–24886. [Google Scholar] [CrossRef]
- De la Rosa-García, S.C.; Martínez-Torres, P.; Gómez-Cornelio, S.; Corral-Aguado, M.A.; Quintana, P.; Gómez-Ortíz, N.M. Antifungal activity of ZnO and MgO nanomaterials and their mixtures against Colletotrichum gloeosporioides strains from tropical fruit. J. Nanomater. 2018, 2018, 3498527. [Google Scholar] [CrossRef]
- Safaei, M.; Taran, M. Preparation of bacterial cellulose fungicide nanocomposite incorporated with MgO nanoparticles. J. Polym. Environ. 2022, 30, 2066–2076. [Google Scholar] [CrossRef]
- Khatua, A.; Kumari, K.; Khatak, D.; Roy, A.; Bhatt, N.; Paul, B.; Naik, A.; Patel, A.K.; Panigrahi, U.K.; Sahu, S.K.; et al. synthesis and spectral characterisation of fabricated cerium-doped magnesium oxide nanoparticles: Evaluation of the antimicrobial potential and its membranolytic activity through large unilamellar vesicles. J. Funct. Biomater. 2023, 14, 112. [Google Scholar] [CrossRef] [PubMed]
- Sidhu, A.; Bala, A.; Singh, H.; Ahuja, R.; Kumar, A. Development of MgO-sepiolite nanocomposites against phytopathogenic fungi of rice (Oryzae sativa): A green approach. ACS Omega 2020, 5, 13557–13565. [Google Scholar] [CrossRef] [PubMed]
- Wang, H.; Li, G.; Fakhri, A. Fabrication and structural of the Ag2S-MgO/graphene oxide nanocomposites with high photocatalysis and antimicrobial activities. J. Photochem. Photobiol. B 2020, 207, 111882. [Google Scholar] [CrossRef] [PubMed]
- Sharmila, G.; Muthukumaran, C.; Sangeetha, E.; Saraswathi, H.; Soundarya, S.; Kumar, N.M. Green fabrication, characterization of Pisonia alba leaf extract derived MgO nanoparticles and its biological applications. Nano-Struct. Nano-Objects 2019, 20, 100380. [Google Scholar] [CrossRef]
- Saied, E.; Eid, A.M.; Hassan, S.E.; Salem, S.S.; Radwan, A.A.; Halawa, M.; Saleh, F.M.; Saad, H.A.; Saied, E.M.; Fouda, A. The catalytic activity of biosynthesized magnesium oxide nanoparticles (MgO-NPs) for inhibiting the growth of pathogenic microbes. Catalysts 2021, 11, 821. [Google Scholar] [CrossRef]
- Fouda, A.; Awad, M.A.; Eid, A.M.; Saied, E.; Barghoth, M.G.; Hamza, M.F.; Awad, M.F.; Abdelbary, S.; Hassan, S.E.-D. An eco-friendly approach to the control of pathogenic microbes and Anopheles stephensi malarial vector using magnesium oxide nanoparticles (Mg-NPs) fabricated by Penicillium chrysogenum. Int. J. Mol. Sci. 2021, 22, 5096. [Google Scholar] [CrossRef] [PubMed]
- Sulak, M.; Kavakcıoğlu Yardımcı, B. The green synthesis of MgO nanoparticles using dried jujube fruit extract and their anti-yeast activity against Saccharomyces cerevisiae. Inorg. Nano-Met. Chem. 2021, 52, 653–660. [Google Scholar] [CrossRef]
- Vidhya, E.; Vijayakumar, S.; Nilavukkarasi, M.; Punitha, V.N.; Snega, S.; Praseetha, P.K. Green fabricated MgO nanoparticles as antimicrobial agent: Characterization and evaluation. Mater. Today Proc. 2021, 45, 5579–5583. [Google Scholar] [CrossRef]
- Vijayakumar, S.; Punitha, V.N.; Parameswari, N. Phytonanosynthesis of MgO Nanoparticles: Green Synthesis, Characterization and Antimicrobial Evaluation. Arab. J. Sci. Eng. 2021, 47, 6729–6734. [Google Scholar] [CrossRef]
- Al-Fahdawi, M.Q.; Rasedee, A.; Al-Doghachi, F.A.; Rosli, R.; Taufiq-Yap, Y.H.; Al-Qubaisi, M.S. Anticancer palladium-doped magnesia nanoparticles: Synthesis, characterization, and in vitro study. Nanomedicine 2020, 15, 547–561. [Google Scholar] [CrossRef]
- van der Valk, M.J.M.; Marijnen, C.A.M.; van Etten, B.; Dijkstra, E.A.; Hilling, D.E.; Kranenbarg, E.M.-K.; Putter, H.; Roodvoets, A.G.H.; Bahadoer, R.R.; Fokstuen, T.; et al. Compliance and tolerability of short-course radiotherapy followed by preoperative chemotherapy and surgery for high-risk rectal cancer—Results of the international randomized RAPIDO-trial. Radiother. Oncol. 2020, 147, 75–83. [Google Scholar] [CrossRef]
- Hussain, Y.; Islam, L.; Khan, H.; Filosa, R.; Aschner, M.; Javed, S. Curcumin-isplatin chemotherapy: A novel strategy in promoting chemotherapy efficacy and reducing side effects. Phyther. Res. 2021, 35, 6514–6529. [Google Scholar] [CrossRef]
- Behzadi, E.; Sarsharzadeh, R.; Nouri, M.; Attar, F.; Akhtari, K.; Shahpasand, K.; Falahati, M. Albumin binding and anticancer effect of magnesium oxide nanoparticles. Int. J. Nanomed. 2018, 14, 257–270. [Google Scholar] [CrossRef]
- Alfaro, A.; León, A.; Guajardo-Correa, E.; Reúquen, P.; Torres, F.; Mery, M.; Segura, R.; Zapata, P.A.; Orihuela, P.A. MgO nanoparticles coated with polyethylene glycol as carrier for 2-Methoxyestradiol anticancer drug. PLoS ONE 2019, 14, e0214900. [Google Scholar] [CrossRef]
- Safaei, M.; Taran, M.; Rezaei, R.; Mansouri, K.; Mozaffari, H.; Imani, M.; Sharifi, R. Synthesis and anticancer properties of bacterial cellulose-magnesium oxide bionanocomposite. Curr. Issues Pharm. Med. Sci. 2019, 32, 29–33. [Google Scholar] [CrossRef]
- Al-Fahdawi, M.Q.; Al-Doghachi, F.A.J.; Abdullah, Q.K.; Hammad, R.T.; Rasedee, A.; Ibrahim, W.N.; Alshwyeh, H.A.; Alosaimi, A.A.; Aldosary, S.K.; Eid, E.E.M.; et al. Oxidative stress cytotoxicity induced by platinum-doped magnesia nanoparticles in cancer cells. Biomed. Pharmacother. 2021, 138, 111483. [Google Scholar] [CrossRef]
- MubarakAli, D.; Manzoor, M.A.P.; Sabarinathan, A.; Devi, C.A.; Rekha, P.D.; Thajuddin, N.; Lee, S.-Y. An investigation of antibiofilm and cytotoxic property of MgO nanoparticles. Biocatal. Agric. Biotechnol. 2019, 18, 101069. [Google Scholar] [CrossRef]
- Chen, K.; Abdtawfeeq, T.H.; Kadhim, I.K.; Jawad, M.A.; Hammad, M.J.; Mohammed, N.M.; Riyahi, Y.; Hadrawi, S.K.; Kaur, J.; Soltani, A. Magnesium oxide nanotube as novel strategies to enhance the anticancer activity of 5-Fluorouracil. J. Mol. Liq. 2023, 384, 122214. [Google Scholar] [CrossRef]
- Singh, T.A.; Sadhukhan, P.; Ghosh, N.; Thakur, N.; Sharma, A.; Tejwan, N.; Pabbathi, A.; Das, J.; Sil, P.C. Targeted delivery of rutin into breast cancer cells via using phenylboronic acid functionalized MgO nanoparticles. Mater. Sci. Eng. B 2023, 296, 116623. [Google Scholar] [CrossRef]
- Kgosiemang, I.K.; Lefojane, R.; Direko, P.; Madlanga, Z.; Mashele, S.; Sekhoacha, M. Green synthesis of magnesium and cobalt oxide nanoparticles using Euphorbia tirucalli: Characterization and potential application for breast cancer inhibition. Inorg. Nano-Met. Chem. 2020, 50, 1070–1080. [Google Scholar] [CrossRef]
- Abdullah, O.H.; Mohammed, A.M. Biosynthesis and characterization of MgO nanowires using Prosopis farcta and evaluation of their applications. Inorg. Chem. Commun. 2021, 125, 108435. [Google Scholar] [CrossRef]
- Fathy, R.M.; Mahfouz, A.Y. Eco-friendly graphene oxide-based magnesium oxide nanocomposite synthesis using fungal fermented by-products and gamma rays for outstanding antimicrobial, antioxidant, and anticancer activities. J. Nanostruct. Chem. 2021, 11, 301–321. [Google Scholar] [CrossRef]
- Kainama, H.; Fatmawati, S.; Santoso, M.; Papilaya, P.M.; Ersam, T. The relationship of free radical scavenging and total phenolic and flavonoid contents of Garcinia lasoar PAM. Pharm. Chem. J. 2020, 53, 1151–1157. [Google Scholar] [CrossRef]
- Li, C.-W.; Li, L.-L.; Chen, S.; Zhang, J.-X.; Lu, W.-L. Antioxidant nanotherapies for the treatment of inflammatory diseases. Front. Bioeng. Biotechnol. 2020, 8, 200. [Google Scholar] [CrossRef]
- Podder, S.; Chanda, D.; Mukhopadhyay, A.K.; De, A.; Das, B.; Samanta, A.; Hardy, J.G.; Ghosh, C.K. Effect of morphology and concentration on crossover between antioxidant and pro-oxidant activity of MgO nanostructures. Inorg. Chem. 2018, 57, 12727–12739. [Google Scholar] [CrossRef] [PubMed]
- Ali, S.; Sudha, K.G.; Thirumalaivasan, N.; Ahamed, M.; Pandiaraj, S.; Rajeswari, V.D.; Vinayagam, Y.; Thiruvengadam, M.; Govindasamy, R. Green synthesis of magnesium oxide nanoparticles by using Abrus precatorius bark extract and their photocatalytic, antioxidant, antibacterial, and cytotoxicity activities. Bioengineering 2023, 10, 302. [Google Scholar] [CrossRef]
- Mylarappa, M.; Rekha, S.; Kantharaju, S.; Chandruvasan, S.; Shravana, K. Synthesis and characterization of ZnO and MgO nanoparticles through green approach and their antioxidant properties. ECS Trans. 2022, 107, 689. [Google Scholar] [CrossRef]
- Priya, P.; Elumali, K.; Shakila, D.; Geetha, K.; Dinesh Karthik, A. Facile approach to synthesize, compared to MgO & ZnO nanoparticles by using Clitoria ternatea/Tecoma castanifolia flower. Mater. Today Proc. 2020, 29, 1217–1222. [Google Scholar] [CrossRef]
- Ammulu, M.A.; Vinay Viswanath, K.; Giduturi, A.K.; Vemuri, P.K.; Mangamuri, U.; Poda, S. Phytoassisted synthesis of magnesium oxide nanoparticles from Pterocarpus marsupium rox.b heartwood extract and its biomedical applications. J. Genet. Eng. Biotechnol. 2021, 19, 21. [Google Scholar] [CrossRef]
- Nadeem, A.; Sumbal Ali, J.S.; Latif, M.; Rizvi, Z.F.; Naz, S.; Mannan, A.; Zia, M. Green synthesis and characterization of Fe, Cu and Mg oxide nanoparticles using Clematis orientalis leaf extract: Salt concentration modulates physiological and biological properties. Mater. Chem. Phys. 2021, 271, 124900. [Google Scholar] [CrossRef]
- American Diabetes Association. Classification and Diagnosis of Diabetes: Standards of Medical Care in Diabetes—2018. Diabetes Care 2018, 41 (Suppl. S1), S13–S27. [Google Scholar] [CrossRef]
- Szunerits, S.; Melinte, S.; Barras, A.; Pagneux, Q.; Voronova, A.; Abderrahmani, A.; Boukherroub, R. The impact of chemical engineering and technological advances on managing diabetes: Present and future concepts. Chem. Soc. Rev. 2021, 50, 2102–2146. [Google Scholar] [CrossRef]
- Debele, T.A.; Park, Y. Application of Nanoparticles: Diagnosis, Therapeutics, and Delivery of Insulin/Anti-Diabetic Drugs to Enhance the Therapeutic Efficacy of Diabetes Mellitus. Life 2022, 12, 2078. [Google Scholar] [CrossRef]
- Repaske, D.R. Medication-induced diabetes mellitus. Pediatr. Diabetes 2016, 17, 392–397. [Google Scholar] [CrossRef]
- Lagopati, N.; Valamvanos, T.-F.; Proutsou, V.; Karachalios, K.; Pippa, N.; Gatou, M.-A.; Vagena, I.-A.; Cela, S.; Pavlatou, E.A.; Gazouli, M.; et al. The Role of Nano-Sensors in Breath Analysis for Early and Non-Invasive Disease Diagnosis. Chemosensors 2023, 11, 317. [Google Scholar] [CrossRef]
- Lemmerman, L.R.; Das, D.; Higuita-Castro, N.; Mirmira, R.G.; Gallego-Perez, D. Nanomedicine-Based Strategies for Diabetes: Diagnostics, Monitoring, and Treatment. Trends Endocrinol. Metab. 2021, 31, 448–458. [Google Scholar] [CrossRef] [PubMed]
- Lagopati, N.; Pavlatou, E.A. Nanotechnology in Diabetes Management. Interv. Obes. Diabetes 2021, 5, 419–424. [Google Scholar] [CrossRef]
- Tang, L.; Chang, S.J.; Chen, C.-J.; Liu, J.-T. Non-Invasive Blood Glucose Monitoring Technology: A Review. Sensors 2020, 20, 6925. [Google Scholar] [CrossRef] [PubMed]
- Rydosz, A. Nanosensors for exhaled breath monitoring as a possible tool for noninvasive diabetes detection. In Nanosensors for Smart Cities; Kumar Singh, P., Ed.; Elsevier: Amsterdam, The Netherlands, 2020; pp. 467–481. [Google Scholar]
- Hilal, M.; Han, J.I. Facile preparation of three-dimensional hierarchical MgO microstructures for non-enzymatic glucose sensor. Appl. Surf. Sci. 2023, 619, 156750. [Google Scholar] [CrossRef]
- Mansoor, S.; Shahid, S.; Ashiq, K.; Alwadai, N.; Javed, M.; Iqbal, S.; Fatima, U.; Zaman, S.; Sarwar, M.N.; Alshammari, F.H.; et al. Controlled growth of nanocomposite thin layer based on Zn-Doped MgO nanoparticles through sol-gel technique for biosensor applications. Inorg. Chem. Commun. 2022, 142, 109702. [Google Scholar] [CrossRef]
- Prasanna, A.P.S.; Kuppuswamy, G.P.; Pradeep, N.; Surya, V.J.; Sivalingam, Y. Enzyme free detection of glucose using MgO nanocubes based extended gate N-channel MOSFET. IOP Conf. Ser. Mater. Sci. Eng. 2022, 1219, 012030. [Google Scholar] [CrossRef]
- Tan, K.X.; Jeevanandam, J.; Pan, S.; Yon, L.S.; Danquah, M.K. Aptamer-navigated copolymeric drug carrier system for in vitro delivery of MgO nanoparticles as insulin resistance reversal drug candidate in Type 2 diabetes. J. Drug Deliv. Sci. Technol. 2020, 57, 01764. [Google Scholar] [CrossRef]
- Jeevanandam, J.; Chan, Y.S.; Danquah, M.K. Cytotoxicity and insulin resistance reversal ability of biofunctional phytosynthesized MgO nanoparticles. 3 Biotech 2020, 10, 489. [Google Scholar] [CrossRef]
- Navarro, M.; Michiardi, A.; Castano, O.; Planell, J.A. Biomaterials in orthopaedics. J. R. Soc. Interface 2008, 5, 1137–1158. [Google Scholar] [CrossRef]
- Deng, M.; James, R.; Laurencin, C.T.; Kumbar, S.G. Nanostructured polymeric scaffolds for orthopaedic regenerative engineering. IEEE Trans. NanoBiosci. 2012, 11, 3–14. [Google Scholar] [CrossRef]
- Smith, I.O.; Liu, X.H.; Smith, L.A.; Ma, P.X. Nano-structured polymer scaffolds for tissue engineering and regenerative medicine. Wiley Interdiscip. Rev. Nanomed. Nanobiotechnol. 2009, 1, 226–236. [Google Scholar] [CrossRef]
- Laurencin, C.T.; Ambrosio, A.M.A.; Borden, M.D.; Cooper Jr, J.A. Tissue engineering: Orthopedic applications. Ann. Rev. Biomed. Eng. 1999, 1, 19–46. [Google Scholar] [CrossRef]
- Tien, Y.C.; Chih, T.T.; Lin, J.H.; Ju, C.P.; Lin, S.D. Augmentation of tendon-bone healing by the use of calcium-phosphate cement. J. Bone Jt. Surg. Br. 2004, 86, 1072–1076. [Google Scholar] [CrossRef]
- Huangfu, X.; Zhao, J. Tendon-bone healing enhancement using injectable tricalcium phosphate in a dog anterior cruciate ligament reconstruction model. Arthroscopy 2007, 23, 455–462. [Google Scholar] [CrossRef]
- Dvir, T.; Timko, B.P.; Kohane, D.S.; Langer, R. Nanotechnological strategies for engineering complex tissues. Nat. Nanotechnol. 2011, 6, 13–22. [Google Scholar] [CrossRef]
- Maguire, M.E.; Cowan, J.A. Magnesium chemistry and biochemistry. Biometals 2002, 15, 203–210. [Google Scholar] [CrossRef] [PubMed]
- Hickey, D.J.; Ercan, B.; Sun, L.; Webster, T.J. Adding MgO nanoparticles to hydroxyapatite–PLLA nanocomposites for improved bone tissue engineering applications. Acta Biomater. 2015, 14, 175–184. [Google Scholar] [CrossRef] [PubMed]
- Suryavanshi, A.; Khanna, K.; Sindhu, K.R.; Bellare, J.; Srivastava, R. Magnesium oxide nanoparticle-loaded polycaprolactone composite electrospun fiber scaffolds for bone-soft tissue engineering applications: In-vitro and in-vivo evaluation. Biomed. Mater. 2017, 12, 055011. [Google Scholar] [CrossRef] [PubMed]
- Safiaghdam, H.; Nokhbatolfoghahaei, H.; Farzad-Mohajeri, S.; Dehghan, M.M.; Farajpour, H.; Aminianfar, H.; Bakhtiari, Z.; Jabbari Fakhr, M.; Hosseinzadeh, S.; Khojasteh, A. 3D-printed MgO nanoparticle loaded polycaprolactone β-tricalcium phosphate composite scaffold for bone tissue engineering applications: In-vitro and in-vivo evaluation. J. Biomed. Mater. Res. 2023, 111, 322–339. [Google Scholar] [CrossRef] [PubMed]
- Nasri-Nasrabadi, B.; Kaynak, A.; Heidarian, P.; Komeily-Nia, Z.; Mehrasa, M.; Salehi, H.; Kouzani, A.Z. Sodium alginate/magnesium oxide nanocomposite scaffolds for bone tissue engineering. Polym. Adv. Technol. 2018, 29, 2553–2559. [Google Scholar] [CrossRef]
- Singh, A.K.; Pramanik, K.; Biswas, A. MgO enables enhanced bioactivity and antimicrobial activity of nano bioglass for bone tissue engineering application. Mater. Technol. 2019, 34, 818–826. [Google Scholar] [CrossRef]
- Canales, D.A.; Reyes, F.; Saavedra, M.; Peponi, L.; Leonés, A.; Palza, H.; Boccaccini, A.R.; Grünewald, A.; Zapata, P.A. Electrospun fibers of poly (lactic acid) containing bioactive glass and magnesium oxide nanoparticles for bone tissue regeneration. Int. J. Biol. Macromol. 2022, 210, 324–336. [Google Scholar] [CrossRef] [PubMed]
- Ghanbari, E.; Khazaei, M.; Mehdipour, A.; Khoshfeterat, A.; Niknafs, B. Green synthesized magnesium oxide nanoparticles reinforce osteogenesis properties of bacterial cellulose scaffolds for bone tissue engineering applications: An in vitro assessment. Cell J. 2023, 25, 483–495. [Google Scholar] [CrossRef] [PubMed]
- Roh, H.S.; Lee, C.M.; Hwang, Y.H.; Kook, M.S.; Yang, S.W.; Lee, D.; Kim, B.H. Addition of MgO nanoparticles and plasma surface treatment of three-dimensional printed polycaprolactone/hydroxyapatite scaffolds for improving bone regeneration. Mater. Sci. Eng. C Mater. Biol. Appl. 2017, 74, 525–535. [Google Scholar] [CrossRef] [PubMed]
- Angili, S.N.; Morovvati, M.R.; Kardan-Halvaei, M.; Saber-Samandari, S.; Razmjooee, K.; Abed, A.M.; Toghraie, D.; Khandan, A. Fabrication and finite element simulation of antibacterial 3D printed Poly L-lactic acid scaffolds coated with alginate/magnesium oxide for bone tissue regeneration. Int. J. Biol. Macromol. 2023, 224, 1152–1165. [Google Scholar] [CrossRef]
- Niknam, Z.; Golchin, A.; Rezaei-Tavirani, M.; Ranjbarvan, P.; Zali, H.; Omidi, M.; Mansouri, V. Osteogenic differentiation potential of adipose-derived mesenchymal stem cells cultured on magnesium oxide/polycaprolactone nanofibrous scaffolds for improving bone tissue reconstruction. Adv. Pharm. Bull. 2022, 12, 142–154. [Google Scholar] [CrossRef]
- MacNeil, S. Biomaterials for tissue engineering of skin. Mater. Today 2008, 11, 26–35. [Google Scholar] [CrossRef]
- Broughton, G.; Janis, J.E.; Attinger, C.E. The basic science of wound healing. Plast. Reconstr. Surg. 2006, 117, 12S–34S. [Google Scholar] [CrossRef]
- Diegelmann, R.F.; Evans, M.C. Wound healing: An overview of acute, fibrotic and delayed healing. Front. Biosci. 2004, 1, 283–289. [Google Scholar] [CrossRef]
- Gosain, A.; DiPietro, L.A. Aging and wound healing. World J. Surg. 2004, 28, 321–326. [Google Scholar] [CrossRef]
- Boateng, J.S.; Matthews, K.H.; Stevens, H.N.; Eccleston, G.M. Wound healing dressings and drug delivery systems: A review. J. Pharm. Sci. 2008, 97, 2892–2923. [Google Scholar] [CrossRef]
- Jiang, Q.; Zhou, W.; Wang, J.; Tang, R.; Zhang, D.; Wang, X. Hypromellose succinate-crosslinked chitosan hydrogel films for potential wound dressing. Int. J. Biol. Macromol. 2016, 91, 85–91. [Google Scholar] [CrossRef]
- Wen, Y.; Oh, J.K. Recent strategies to develop polysaccharide-based nanomaterials for biomedical applications. Macromol. Rapid Commun. 2014, 35, 1819–1832. [Google Scholar] [CrossRef]
- Nishchay, V.; Krishna, P.; Amit, K.S.; Amit, B. Design of magnesium oxide nanoparticle incorporated carboxy methyl cellulose/poly vinyl alcohol composite film with novel composition for skin tissue engineering. Mater. Technol. 2022, 37, 706–716. [Google Scholar] [CrossRef]
- Davis, M.E.; Chen, Z.G.; Shin, D.M. Nanoparticle therapeutics: An emerging treatment modality for cancer. Nat. Rev. Drug Discov. 2008, 7, 771–782. [Google Scholar] [CrossRef] [PubMed]
- Petros, R.A.; DeSimone, J.M. Strategies in the design of nanoparticles for therapeutic applications. Nat. Rev. Drug Discov. 2010, 9, 615–627. [Google Scholar] [CrossRef]
- Wolfbeis, O.S. An overview of nanoparticles commonly used in fluorescent bioimaging. Chem. Soc. Rev. 2015, 44, 4743–4768. [Google Scholar] [CrossRef] [PubMed]
- Monici, M. Cell and tissue autofluorescence research and diagnostic applications. Biotechnol. Annu. Rev. 2005, 11, 227–256. [Google Scholar] [CrossRef]
- Vahrmeijer, A.L.; Hutteman, M.; van der Vorst, J.R.; van de Velde, C.J.; Frangioni, J.V. Image-guided cancer surgery using near-infrared fluorescence. Nat. Rev. Clin. Oncol. 2013, 10, 507–518. [Google Scholar] [CrossRef]
- Dempsey, G.T.; Vaughan, J.C.; Chen, K.H.; Bates, M.; Zhuang, X. Evaluation of fluorophores for optimal performance in localization-based super-resolution imaging. Nat. Methods 2011, 8, 1027–1036. [Google Scholar] [CrossRef]
- Kairdolf, B.A.; Smith, A.M.; Stokes, T.H.; Wang, M.D.; Young, A.D.; Nie, S. Semiconductor quantum dots for bioimaging and biodiagnostic applications. Annu. Rev. Anal. Chem. 2013, 6, 143–162. [Google Scholar] [CrossRef]
- Khalid, A.; Norello, R.; Abraham, A.N.; Tetienne, J.-P.; Karle, T.J.; Lui, E.W.C.; Xia, K.; Tran, P.A.; O’Connor, A.J.; Mann, B.G.; et al. Biocompatible and Biodegradable Magnesium Oxide Nanoparticles with In Vitro Photostable Near-Infrared Emission: Short-Term Fluorescent Markers. Nanomaterials 2019, 9, 1360. [Google Scholar] [CrossRef] [PubMed]
- Rasheed, P.A.; Sandhyarani, N. Synthesis of Luminescent MgO Nanocrystals and Their Application in Bioimaging. Adv. Sci. Eng. Med. 2014, 6, 283–289. [Google Scholar] [CrossRef]
- Xie, S.; Bao, S.; Ouyang, J.; Zhou, X.; Kuang, Q.; Xie, Z.; Zheng, L. Organic–Inorganic Interface-Induced Multi-Fluorescence of MgO Nanocrystal Clusters and Their Applications in Cellular Imaging. Chem. Eur. J. 2014, 20, 5244–5252. [Google Scholar] [CrossRef] [PubMed]
- Zhao, Q.; Liu, J.; Zhu, W.; Sun, C.; Di, D.; Zhang, Y.; Wang, P.; Wang, Z.; Wang, S. Dual-stimuli responsive hyaluronic acid-conjugated mesoporous silica for targeted delivery to CD44-overexpressing cancer cells. Acta Biomater. 2015, 23, 147–156. [Google Scholar] [CrossRef] [PubMed]
- Rostami, M.; Nasab, A.S.; Fasihi-Ramandi, M.; Badiei, A.; Ganjali, M.R.; Nasrabadi, M.R.; Ahmadi, F. Cur-loaded magnetic ZnFe2O4@mZnO-Ox-pg-C3N4 composites as dual pH-and ultrasound responsive nano-carriers for controlled and targeted cancer chemotherapy. Mater. Chem. Phys. 2021, 271, 124863. [Google Scholar] [CrossRef]
- Zamani, M.; Rostami, M.; Aghajanzadeh, M.; Manjili, H.K.; Rostamizadeh, K.; Danafar, H. Mesoporous titanium dioxide@ zinc oxide–graphene oxide nanocarriers for colon-specific drug delivery. J. Mater. Sci. 2018, 53, 1634–1645. [Google Scholar] [CrossRef]
- Toledo, L.; Racine, L.; Pérez, V.; Henríquez, J.P.; Auzely-Velty, R.; Urbano, B.F. Physical nanocomposite hydrogels filled with low concentrations of TiO2 nanoparticles: Swelling, networks parameters and cell retention studies. Mater. Sci. Eng. C 2018, 92, 769–778. [Google Scholar] [CrossRef]
- Rostami, M.; Aghajanzadeh, M.; Zamani, M.; Manjili, H.K.; Danafar, H. Sono-chemical synthesis and characterization of Fe3O4@mTiO2-GO nanocarriers for dual-targeted colon drug delivery. Res. Chem. Intermed. 2018, 44, 1889–1904. [Google Scholar] [CrossRef]
- Mendes, R.G.; Bachmatiuk, A.; Büchner, B.; Cuniberti, G.; Rümmeli, M.H. Carbon nanostructures as multi-functional drug delivery platforms. J. Mater. Chem. B 2013, 1, 401–428. [Google Scholar] [CrossRef]
- Jana, A.; Nguyen, K.T.; Li, X.; Zhu, P.; Tan, N.S.; Ågren, H.; Zhao, Y. Perylene-derived single-component organic nanoparticles with tunable emission: Efficient anticancer drug carriers with real-time monitoring of drug release. ACS Nano 2014, 8, 5939–5952. [Google Scholar] [CrossRef]
- Danhier, F.; Feron, O.; Préat, V. To exploit the tumor microenvironment: Passive and active tumor targeting of nanocarriers for anti-cancer drug delivery. J. Control. Release 2010, 148, 135–146. [Google Scholar] [CrossRef] [PubMed]
- Sabbagh, F.; Muhamad, I.I. Acrylamide-based hydrogel drug delivery systems: Release of Acyclovir from MgO nanocomposite hydrogel. J. Taiwan Inst. Chem. Eng. 2017, 72, 182–193. [Google Scholar] [CrossRef]
- Rostami, M.; Sharafi, P.; Mozaffari, S.; Adib, K.; Sobhani-Nasab, A.; Rahimi-Nasrabadi, M.; Fasihi-Ramandi, M.; Ganjali, M.R.; Badiei, A. A facile preparation of ZnFe2O4–CuO-N/B/RGO and ZnFe2O4–CuO–C3N4 ternary heterojunction nanophotocatalyst: Characterization, biocompatibility, photo-Fenton-like degradation of MO and magnetic properties. J. Mater. Sci. Mater. Electron. 2021, 32, 5457–5472. [Google Scholar] [CrossRef]
- Abinaya, S.; Kavitha, H.P.; Prakash, M.; Muthukrishnaraj, A. Green synthesis of magnesium oxide nanoparticles and its applications: A review. Sustain. Chem. Pharm. 2021, 19, 100368. [Google Scholar] [CrossRef]
- Sabella, S.; Carney, R.P.; Brunetti, V.; Malvindi, M.A.; Al-Juffali, N.; Vecchio, G.; Janes, S.M.; Bakr, O.M.; Cingolani, R.; Stellacci, F. A general mechanism for intracellular toxicity of metal-containing nanoparticles. Nanoscale 2014, 6, 7052–7061. [Google Scholar] [CrossRef] [PubMed]
- Leung, Y.H.; Ng, A.M.; Xu, X.; Shen, Z.; Gethings, L.A.; Wong, M.T.; Chan, C.M.; Guo, M.Y.; Ng, Y.H.; Djurišić, A.B. Mechanisms of antibacterial activity of MgO: Non-ROS mediated toxicity of MgO nanoparticles towards Escherichia coli. Small 2014, 10, 1171–1183. [Google Scholar] [CrossRef] [PubMed]
- Manke, A.; Wang, L.; Rojanasakul, Y. Mechanisms of nanoparticle-induced oxidative stress and toxicity. Biomed. Res. Int. 2013, 2013, 942916. [Google Scholar] [CrossRef] [PubMed]
- Buzea, C.; Pacheco, I.I.; Robbie, K. Nanomaterials and nanoparticles: Sources and toxicity. Biointerphases 2007, 2, MR17–MR71. [Google Scholar] [CrossRef]
- Ge, S.; Wang, G.; Shen, Y.; Zhang, Q.; Jia, D.; Wang, H.; Dong, Q.; Yin, T. Cytotoxic effects of MgO nanoparticles on human umbilical vein endothelial cells in vitro. IET Nanobiotechnol. 2011, 5, 36–40. [Google Scholar] [CrossRef]
- Ghobadian, M.; Nabiuni, M.; Parivar, K.; Fathi, M.; Pazooki, J. Toxic effects of magnesium oxide nanoparticles on early developmental and larval stages of zebrafish (Danio rerio). Ecotoxicol. Environ. Saf. 2015, 122, 260–267. [Google Scholar] [CrossRef]
- Kovrižnych, J.A.; Sotníková, R.; Zeljenková, D.; Rollerová, E.; Szabova, E.; Wimmerová, S. Acute toxicity of 31 different nanoparticles to zebrafish (Danio rerio) tested in adulthood and in early life stages–comparative study. Interdiscip. Toxicol. 2013, 6, 67–73. [Google Scholar] [CrossRef]
- Kumaran, R.S.; Choi, Y.-K.; Singh, V.; Song, H.-J.; Song, K.-G.; Kim, K.J.; Kim, H.J. In vitro cytotoxic evaluation of MgO nanoparticles and their effect on the expression of ROS genes. Int. J. Mol. Sci. 2015, 16, 7551–7564. [Google Scholar] [CrossRef]
- Cao, Y.; Khan, A.; Javan, M.; Baei, M.T.; Tazikeh-Lemeski, E.; Azmoodeh, Z.; Soltani, A.; Heidari, F.; Pishnamazi, M.; Albadarin, A.B. Adsorption behaviour of Uracil on External Surface of MgO Nanotubes: A New Class of Hybrid Nano-Bio Materials. J. Mol. Liq. 2021, 339, 116732. [Google Scholar] [CrossRef]
- Yang, H.; Liu, C.; Yang, D.; Zhang, H.; Xi, Z. Comparative study of cytotoxicity, oxidative stress and genotoxicity induced by four typical nanomaterials: The role of particle size, shape and composition. J. Appl. Toxicol. 2009, 29, 69–78. [Google Scholar] [CrossRef]
- Dudev, T.; Lim, C. Metal binding affinity and selectivity in metalloproteins: Insights from computational studies. Annu. Rev. Biophys. 2008, 37, 97–116. [Google Scholar] [CrossRef] [PubMed]
- Xia, T.; Kovochich, M.; Liong, M.; Madler, L.; Gilbert, B.; Shi, H.; Yeh, J.I.; Zink, J.I.; Nel, A.E. Comparison of the mechanism of toxicity of zinc oxide and cerium oxide nanoparticles based on dissolution and oxidative stress properties. ACS Nano 2008, 2, 2121–2134. [Google Scholar] [CrossRef] [PubMed]
- Xia, T.; Kovochich, M.; Nel, A.E. Impairment of mitochondrial function by particulate matter (PM) and their toxic components: Implications for PM-induced cardiovascular and lung disease. Front. Biosci. 2007, 12, 1238–1246. [Google Scholar] [CrossRef] [PubMed]
- Yamakoshi, Y.; Umezawa, N.; Ryu, A.; Arakane, K.; Miyata, N.; Goda, Y.; Masumizu, T.; Nagano, T. Active oxygen species generated from photoexcited fullerene (C60) as potential medicines: O2−• versus 1O2. J. Am. Chem. Soc. 2003, 125, 12803–12809. [Google Scholar] [CrossRef] [PubMed]
- De Berardis, B.; Civitelli, G.; Condello, M.; Lista, P.; Pozzi, R.; Arancia, G.; Meschini, S. Exposure to ZnO nanoparticles induces oxidative stress and cytotoxicity in human colon carcinoma cells. Toxicol. Appl. Pharmacol. 2010, 246, 116–127. [Google Scholar] [CrossRef]
- Nohl, H.; Gille, L. Lysosomal ROS formation. Redox Rep. 2005, 10, 199–205. [Google Scholar] [CrossRef]
- Wang, G.; Zhang, L.; Zhang, J. A review of electrode materials for electrochemical supercapacitors. Chem. Soc. Rev. 2012, 41, 797–828. [Google Scholar] [CrossRef]
- Gabbay, J.; Borkow, G.; Mishal, J.; Magen, E.; Zatcoff, R.; Shemer-Avni, Y. Copper oxide impregnated textiles with potent biocidal activities. J. Ind. Text. 2006, 35, 323–335. [Google Scholar] [CrossRef]
- Singh, N.; Manshian, B.; Jenkins, G.J.; Griffiths, S.M.; Williams, P.M.; Maffeis, T.G.; Wright, C.J.; Doak, S.H. NanoGenotoxicology: The DNA damaging potential of engineered nanomaterials. Biomaterials 2009, 30, 3891–3914. [Google Scholar] [CrossRef]
- He, X.; Lin, G.X.; Chen, M.G.; Zhang, J.X.; Ma, Q. Protection against chromium (VI)–induced oxidative stress and apoptosis by Nrf2: Recruiting Nrf2 into the nucleus and disrupting the nuclear Nrf2/Keap1 association. Toxicol. Sci. 2007, 98, 298–309. [Google Scholar] [CrossRef] [PubMed]
- Nel, A.; Xia, T.; Mädler, L.; Li, N. Toxic potential of materials at the nanolevel. Science 2006, 311, 622–627. [Google Scholar] [CrossRef] [PubMed]
- Gunawan, C.; Teoh, W.Y.; Marquis, C.P.; Amal, R. Cytotoxic origin of copper (II) oxide nanoparticles: Comparative studies with micron-sized particles, leachate, and metal salts. ACS Nano 2011, 5, 7214–7225. [Google Scholar] [CrossRef] [PubMed]
- Hartwig, A. Metal interaction with redox regulation: An integrating concept in metal carcinogenesis? Free Radic. Biol. Med. 2013, 55, 63–72. [Google Scholar] [CrossRef] [PubMed]
- Cuillel, M.; Chevallet, M.; Charbonnier, P.; Fauquant, C.; Pignot-Paintrand, I.; Arnaud, J.; Cassio, D.; Michaud-Soret, I.; Mintz, E. Interference of CuO nanoparticles with metal homeostasis in hepatocytes under sub-toxic conditions. Nanoscale 2014, 6, 1707–1715. [Google Scholar] [CrossRef]
- Miller, I.S.; Lynch, I.; Dowling, D.; Dawson, K.A.; Gallagher, W.M. Surface-induced cell signaling events control actin rearrangements and motility. J. Biomed. Mater. Res. A 2010, 93, 493–504. [Google Scholar] [CrossRef]
- Soenen, S.J.; Himmelreich, U.; Nuytten, N.; Pisanic, T.R.; Ferrari, A.; De Cuyper, M. Intracellular nanoparticle coating stability determines nanoparticle diagnostics efficacy and cell functionality. Small 2010, 6, 2136–2145. [Google Scholar] [CrossRef] [PubMed]
- Hoyal, C.R.; Giron-Calle, J.; Forman, H.J. The alveolar macrophage as a model of calcium signaling in oxidative stress. J. Toxicol. Environ. Health Part B 1998, 1, 117–134. [Google Scholar] [CrossRef] [PubMed]
- Dolmetsch, R.E.; Xu, K.; Lewis, R.S. Calcium oscillations increase the efficiency and specificity of gene expression. Nature 1998, 392, 933. [Google Scholar] [CrossRef]
- Raddassi, K.; Berthon, B.; Petit, J.-F.; Lemaire, G. Role of calcium in the activation of mouse peritoneal macrophages: Induction of NO synthase by calcium ionophores and thapsigargin. Cell. Immunol. 1994, 153, 443–455. [Google Scholar] [CrossRef] [PubMed]
- Berridge, M.J.; Bootman, M.D.; Lipp, P. Calcium-a life and death signal. Nature 1998, 395, 645–648. [Google Scholar] [CrossRef]
- Hussein, E.M.; Ahmed, S.A.; Mokhtar, A.B.; Elzagawy, S.M.; Yahi, S.H.; Hussein, A.M.; El-Tantawey, F. Antiprotozoal activity of magnesium oxide (MgO) nanoparticles against Cyclospora cayetanensis oocysts. Parasitol. Int. 2018, 67, 666–674. [Google Scholar] [CrossRef]
- Rafiei, S.; Rezatofighi, S.E.; Ardakani, M.R.; Madadgar, O. In vitro anti-foot-and-mouth disease virus activity of magnesium oxide nanoparticles. IET Nanobiotechnol. 2015, 9, 247–251. [Google Scholar] [CrossRef]
- Abinaya, S.; Kavitha, H.P. Magnesium Oxide Nanoparticles: Effective Antilarvicidal and Antibacterial Agents. ACS Omega 2023, 8, 5225–5233. [Google Scholar] [CrossRef]
- Noori, A.J.; Kareem, F.A. The effect of magnesium oxide nanoparticles on the antibacterial and antibiofilm properties of glass-ionomer cement. Heliyon 2019, 5, e02568. [Google Scholar] [CrossRef]
- Sharifian, S.; Loghmani, A.; Nayyerain, S.; Javanbakht, S.; Daneii, P. Application of Magnesium Oxide Nanoparticles in Dentistry: A Literature Review. Eur. J. Gen. Dent. 2023, 12, 001–006. [Google Scholar] [CrossRef]
- Amukarimi, S.; Mozafari, M. Biodegradable magnesium-based biomaterials: An overview of challenges and opportunities. MedComm 2021, 2, 123–144. [Google Scholar] [CrossRef]
- Shahid, S.; Ejaz, A.; Javed, M.; Mansoor, S.; Iqbal, S.; Elkaeed, E.B.; Alzhrani, R.M.; Alsaab, H.O.; Awwad, N.S.; Ibrahium, H.A.; et al. The Anti-Inflammatory and Free Radical Scavenging Activities of Bio-Inspired Nano Magnesium Oxide. Front. Mater. 2022, 9, 875163. [Google Scholar] [CrossRef]
- Bose, S.; Tarafder, S.; Bandyopadhyay, A. Effect of Chemistry on Osteogenesis and Angiogenesis Towards Bone Tissue Engineering Using 3D Printed Scaffolds. Ann. Biomed. Eng. 2017, 45, 261–272. [Google Scholar] [CrossRef] [PubMed]

| Synthetic Approach | Utilized Precursor | Size (nm) | Studied Activity | Reference |
|---|---|---|---|---|
| Co-precipitation | Mg(NO3)2 | 11 | Antibacterial | [92] |
| Co-precipitation | Mg(NO3)2 | 14–16 | Antibacterial | [93] |
| Co-precipitation | Mg(NO3)2 | 78 | Antibacterial | [94] |
| Sol-gel | Mg(OCH3)2 | 200–300 | - | [100] |
| Sol-gel | Mg(OCH3)2 | ≈8 | - | [101] |
| Solvothermal | Mg(CH3COO)2 | 6 | Antibacterial | [84] |
| Solvothermal | Mg | 18 | Antibacterial | [106] |
| Combustion | Mg(NO3)2 | 20–35 | Antibacterial | [113] |
| Green (plant-mediated) | Mg(NO3)2 | 10 | Antibacterial | [134] |
| Green (plant-mediated) | Bulk MgO | ≈9 | Antibacterial | [135] |
| Green (plant-mediated) | Mg(NO3)2 | <20 | Antibacterial | [136] |
| Green (plant-mediated) | MgCl2 | ≈21 | Antibacterial | [137] |
| Green (plant-mediated) | - | - | Antibacterial | [138] |
| Green (plant-mediated) | Mg(NO3)2 | 30 and 42 | Antioxidant and antibacterial | [142] |
| Green (plant-mediated) | Mg(NO3)2 | 18.2 and 16.5 | Antibacterial | [143] |
| Green (algae-mediated) | Mg(NO3)2·6H2O | 68.6 | Antimicrobial | [144] |
| Green (bacteria-mediated) | Mg(NO3)2 | 30 | Anticancer | [145] |
| Green (fungi-mediated) | MgCl2 | 43–91 | Antibacterial | [146] |
| Synthetic Approach | Main Remarks | Reference |
|---|---|---|
| Microwave-assisted |
| [152] |
| Wet chemical |
| [154] |
| Wet chemical |
| [156] |
| Microwave-assisted & Hydrothermal |
| [82] |
| Green (plant-mediated) |
| [157] |
| Green (plant-mediated) |
| [132] |
| Green (plant-mediated) |
| [158] |
| Green (plant-mediated) |
| [159] |
| Green (plant-mediated) |
| [134] |
| Synthetic Approach | Main Remarks | Reference |
|---|---|---|
| Sol-gel |
| [24] |
| Sol-gel |
| [162] |
| Co-precipitation |
| [163] |
| Co-precipitation |
| [164] |
| Co-precipitation |
| [165] |
| Green (plant-mediated) |
| [168] |
| Green (algae-mediated) |
| [144] |
| Green (plant-mediated) |
| [13] |
| Green (fungi-mediated) |
| [169] |
| Green (plant-mediated) |
| [171] |
| Green (plant-mediated) |
| [172] |
| Green (plant-mediated) |
| [173] |
| Synthetic Approach | Main Remarks | Reference |
|---|---|---|
| Commercially available MgO nanoparticles |
| [177] |
| Sol-gel |
| [178] |
| Precipitation |
| [180] |
| Co-precipitation |
| [181] |
| Microwave-assisted |
| [183] |
| Green (algae-mediated) |
| [144] |
| Green (plant-mediated) |
| [13] |
| Green (plant-mediated) |
| [184] |
| Green (plant-mediated) |
| [185] |
| Green (fungi-mediated) |
| [186] |
| Synthetic Approach | Main Remarks | Reference |
|---|---|---|
| Wet chemical (nanoparticles) |
| [189] |
| Hydrothermal (nanoplates) |
| |
| Hydrothermal (nanorods) |
| |
| Green (plant-mediated) |
| [190] |
| Green (plant-mediated) |
| [192] |
| Green (plant-mediated) |
| [193] |
| Green (plant-mediated) |
| [134] |
| Green (plant-mediated) |
| [194] |
| Green (plant-mediated) |
| [159] |
| Synthetic Approach | Main Remarks | Reference |
|---|---|---|
| Hydrothermal |
| [204] |
| Sol-gel |
| [205] |
| Anodization & Chemical Bath Deposition |
| [85] |
| Thermal CVD |
| [206] |
| Green (plant-mediated) |
| [207] |
| Green (plant-mediated) |
| [208] |
| ||
| ||
| Green (plant-mediated) |
| [194] |
| Green (plant-mediated) |
| [158] |
| Proposed MgO-Based Material | Main Remarks | Reference |
|---|---|---|
| Bone tissue engineering | ||
| MgO-HA-PLLA nanocomposite |
| [217] |
| MgO-PCL nanocomposite fibers |
| [218] |
| PCL/β-TCP/nano-MgO scaffolds |
| [219] |
| MgO-bioglass nanoparticles |
| [221] |
| MgO nanoparticles-BC scaffold |
| [223] |
| PLA/alginate/MgO scaffold |
| [225] |
| MgO/PCL nanofibrous scaffolds |
| [226] |
| Skin tissue engineering | ||
| CMC/PVA/MgO composite films |
| [234] |
| PCL/gelatin/MgO membrane |
| [29] |
Disclaimer/Publisher’s Note: The statements, opinions and data contained in all publications are solely those of the individual author(s) and contributor(s) and not of MDPI and/or the editor(s). MDPI and/or the editor(s) disclaim responsibility for any injury to people or property resulting from any ideas, methods, instructions or products referred to in the content. |
© 2024 by the authors. Licensee MDPI, Basel, Switzerland. This article is an open access article distributed under the terms and conditions of the Creative Commons Attribution (CC BY) license (https://creativecommons.org/licenses/by/4.0/).
Share and Cite
Gatou, M.-A.; Skylla, E.; Dourou, P.; Pippa, N.; Gazouli, M.; Lagopati, N.; Pavlatou, E.A. Magnesium Oxide (MgO) Nanoparticles: Synthetic Strategies and Biomedical Applications. Crystals 2024, 14, 215. https://doi.org/10.3390/cryst14030215
Gatou M-A, Skylla E, Dourou P, Pippa N, Gazouli M, Lagopati N, Pavlatou EA. Magnesium Oxide (MgO) Nanoparticles: Synthetic Strategies and Biomedical Applications. Crystals. 2024; 14(3):215. https://doi.org/10.3390/cryst14030215
Chicago/Turabian StyleGatou, Maria-Anna, Eirini Skylla, Panagiota Dourou, Natassa Pippa, Maria Gazouli, Nefeli Lagopati, and Evangelia A. Pavlatou. 2024. "Magnesium Oxide (MgO) Nanoparticles: Synthetic Strategies and Biomedical Applications" Crystals 14, no. 3: 215. https://doi.org/10.3390/cryst14030215
APA StyleGatou, M.-A., Skylla, E., Dourou, P., Pippa, N., Gazouli, M., Lagopati, N., & Pavlatou, E. A. (2024). Magnesium Oxide (MgO) Nanoparticles: Synthetic Strategies and Biomedical Applications. Crystals, 14(3), 215. https://doi.org/10.3390/cryst14030215

